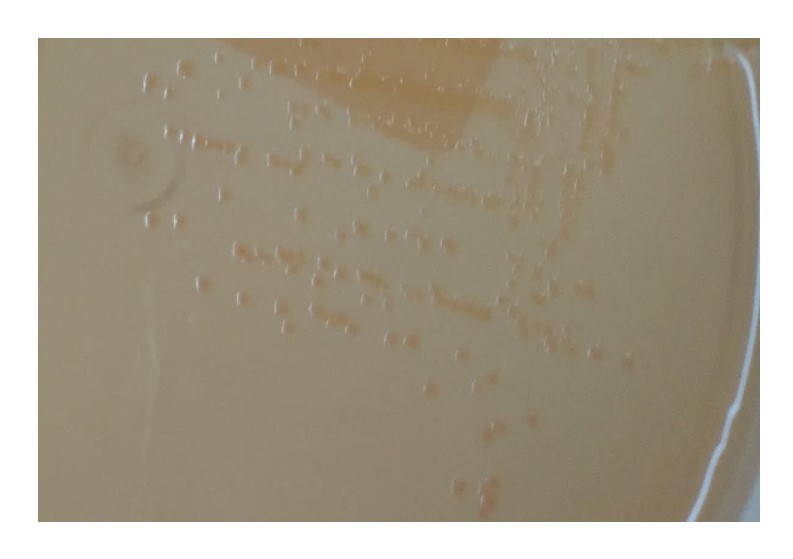

¶ Folha de rosto
© 2024 Ministério da Agricultura e Pecuária. Todos os direitos reservados. É permitida a reprodução parcial ou total desta obra, desde que citada a fonte e que não seja para venda ou qualquer fim comercial. A responsabilidade pelos direitos autorais de textos e imagens desta obra é do autor.
Ano 2024
Elaboração, distribuição, informações:
Ministério da Agricultura e Pecuária
Secretaria de Defesa Agropecuária - SDA
Departamento de Serviços Técnicos - DTEC
Esplanada dos Ministérios, Bloco D, Anexo, Ala B, 4º andar, sala 433
CEP: 70043-900, Brasília - DF
www.agricultura.gov.br
e- mail: cgal@agro.gov.br
Central de Relacionamento: 0800 704 1995
Equipe Técnica:
- Ana Cristina Gonçalves Pinto da Rocha
- Ana Carolina de Oliveira Nascimento
- Anapolino Macedo de Oliveira
- Aerlem Cynara Silva
- Ana Karina Cunha Callado
- Andrea Padilha de Alencar
- Anselmo Vasconcelos Rivetti Júnior
- Antônio Augusto Fonseca Júnior
- Cid Aristóteles de Siqueira Alencar
- Dilmara Reischak
- Fernanda Gomes Cardoso
- Isabela Ciarlini de Azevedo
- João Marcos Nacif da Costa
- Juliana Nabuco Pereira Otaka
- Luanda Bispo Santos do Nascimento Maués
- Luciana Amaral Pinto
- Luciana Rabello Ferreira
- Luciana Taborda Corrêa
- Marcelo Fernandes Camargos
- Marco Antônio de Carvalho Marques Serqueira
- Paulo Martins Soares Filho
- Patrícia Gomes de Souza
- Rene Ribeiro da Silva
- Sheila de Matos Xavier
- Silvio Orlan de Castro Chaves
- Soraya Cecilia Albieri Camillo
¶ Folha resumo
|
Macroprocesso: Laboratórios |
Objetivo: Realizar a padronização, harmonização, atualização e a unificação dos procedimentos para execução de ensaios laboratoriais da área de Diagnóstico Animal |
|||
|
Processo: Análises Laboratoriais |
||||
|
Entrega: Segurança e saúde dos rebanhos animais |
Público alvo e demais interessados: Laboratórios oficiais ou credenciados do Ministério da Agricultura e Pecuária (Mapa) |
Versão do documento: 1 |
||
|
Setor responsável e responsabilidades A Coordenação Geral de Laboratórios Agropecuários do Departamento de Serviços Técnicos é responsável pela elaboração, atualização e envio para aprovação deste manual, tendo responsabilidade quanto aos procedimentos descritos no documento. |
||||
¶ 1. Definições e conceitos
Não aplicável
¶ 2. Responsabilidades
O presente manual possui vigência e prazo indeterminado e será revisado sempre que necessário, no mínimo anualmente, pela Coordenação Geral de Laboratórios Agropecuários do Departamento de Serviços Técnicos (CGAL/DTEC).
A gestão desse manual está sob a responsabilidade da CGAL/DTEC que prestará auxílio ao público alvo leitor dúvidas e/ou sugestões quanto à aplicação deste manual devem ser submetidas ao Departamento responsável.
A publicação e atualização das versões na plataforma oficial da SDA para acesso pelo público alvo será de responsabilidade da Secretaria representada pelo DTEC.
¶ 3. Objetivo
O objetivo do Manual é reunir os métodos analíticos a serem empregados na execução de ensaios laboratoriais da área de Diagnóstico Animal da Rede Nacional de Laboratórios Agropecuários (Rede LFDA e Laboratórios credenciados junto ao Ministério da Agricultura e Pecuária).
¶ 4. Procedimentos - Aves
¶ 4.1 Salmonelose Aviária
4.1.1.Amostras
São consideradas amostras para o diagnóstico da Salmonelose Aviária:
4.1.1.1. Detecção da Resposta Imune
Soro sanguíneo.
4.1.1.2. Identificação do Agente
a) Material Fecal
I.Mecônio; e
II.Fezes frescas.
b) Material Ambiental e suabes
I.Suabe de arrasto;
II.Propé;
III.Suabe de fundo de caixa;
IV.Papel de fundo de caixa;
V.Suabe de cloaca; e
VI.Poeira de aviário.
c) Órgãos e tecidos
I.Coração;
II.Fígado e vesícula biliar;
III.Baço;
IV.Ceco com tonsilas cecais;
V.Saco da gema; e
VI.Ovário ou gônadas.
d) Ovos bicados, aves mortas e pintos de um dia (órgãos e tecidos)
I.Fígado, baço e vesícula biliar;
II.Saco da gema (quando houver) e
III.Ceco.
Nota: Durante a necropsia, serão obrigatoriamente gerados os três pools distintos (I, II e III), não podendo ser agrupados em nenhum momento da análise.
4.1.1.3. Triagem por Biologia Molecular - PCR
a) Material Fecal
I.Mecônio; e
II.Fezes frescas.
b)Material Ambiental e suabes
I.Suabe de arrasto;
II.Propé;
III.Suabe de fundo de caixa;
IV.Papel de fundo de caixa;
V.Suabe de cloaca; e
VI.Poeira de aviário.
c) Órgãos e tecidos
I.Coração;
II.Fígado e vesícula biliar;
III.Baço;
IV.Ceco com tonsilas cecais;
V.Saco da Gema; e
VI.Ovário ou Gônadas.
d) Ovos bicados, aves mortas e pintos de um dia (órgãos e tecidos)
I.Fígado, baço e vesícula biliar;
II.Saco da gema; e
III.Ceco.
4.1.1.4.Triagem por Biologia Molecular - BAX
a)Gema, Material Fecal e Ambiental
I.Mecônio;
II.Gema;
III.Fezes frescas;
IV.Suabe de Fundo de caixa;
V.Papel de fundo de caixa; e
VI.Suabe de cloaca.
4.1.2.Recebimento das Amostras
4.1.2.1. Para atendimento aos Programas e Controles Oficiais do MAPA os Laboratórios credenciados somente receberão as amostras previstas na legislação em vigor para as finalidades e ensaios previstos no seu escopo de credenciamento.
4.1.2.2. Deverão ser obedecidos os critérios estabelecidos no capítulo de verificação de conformidade de amostras.
4.1.2.3. As amostras deverão ser encaminhadas ao laboratório, individualmente e obedecendo a critérios de biossegurança.
4.1.3.Técnicas de Diagnóstico
4.1.3.1. Somente poderão ser utilizados insumos de diagnóstico que tenham registro no MAPA, segundo Legislação em vigor;
4.1.3.2. Todos os insumos utilizados na análise devem ser controlados e previamente testados e aprovados;
4.1.3.3. O laboratório deverá realizar os ensaios obedecendo às temperaturas preconizadas pelo fabricante dos insumos.
a) Quando esta informação não constar na bula o laboratório deverá consultar o fabricante, mesmo que a indicação seja de realização a temperatura ambiente.
b) Quando não informado pelo fabricante, serão considerados como temperatura ambiente, valores de temperatura entre 18 e 25 °C.
4.1.3.4. Antes da utilização dos insumos, realizar a avaliação de todos os parâmetros referentes aos lotes e valores de ponto de corte dos critérios de interpretação dos resultados;
4.1.3.5. O laboratório deve estabelecer um meio de avaliação apropriado para todos os insumos utilizados nos ensaios;
4.1.3.6. Devem ser retidos os registros dos controles dos ensaios realizados, devendo ser registrada data e responsável de todas as etapas realizadas para cada amostra analisada;
4.1.3.7. Os resultados encontrados para cada amostra e controles, dados dos insumos utilizados e outras informações pertinentes devem ser registrados em formulários próprios e/ou sistema informatizado do próprio laboratório;
Nota: A utilização de sistemas informatizados para registros apenas é permitido quando:
I. A inclusão dos dados for realizada durante a execução e leitura do ensaio, sem anotação prévia em formulários de papel. Dados transcritos não são considerados dados brutos.
II. As alterações de informações estejam prontamente disponíveis e rastreáveis, sem a necessidade de intervenção de especialistas em informática ou geração de logs ou equivalentes.
III. O dado anterior, o responsável pela alteração e a data da realização da alteração estiver prontamente disponível.
4.1.3.8. O laboratório deve identificar no resultado o sorovar que estiver contemplado entre os sorovares da caracterização básica (S. Typhimurium, S. Enteritidis, S. Gallinarum e S. Pullorum) ou da ampliada (S. Typhimurium, S. Enteritidis, S. Gallinarum, S. Pullorum, S. Heidelberg, S. Virchow, S. Hadar e S. Infantis), identificado no escopo de credenciamento e acreditação qual das técnicas utiliza. A identificação dos sorovares não contemplados no Programa Nacional de Sanidade Avícola (PNSA) é opcional e somente pode ser realizada através de tipificação por microarranjo de DNA ou caracterização antigênica completa;
4.1.3.9. A tipificação por microarranjo de DNA poderá ser realizada pelo próprio laboratório ou por laboratório externo, desde que este seja credenciado pelo MAPA com o escopo mínimo para doenças das aves conforme estabelecido capítulo Escopo, Doença das aves;
4.1.3.10. No caso de o laboratório optar pela caracterização antigênica completa, esta somente poderá ser realizada por um dos laboratórios de referência para salmonela como o Instituto Oswaldo Cruz e o Instituto Adolfo Lutz. Os LFDA não prestarão este serviço.
4.1.3.11. O envio de cepas a provedores externos deverá ser previamente acordado.
4.1.3.12. É facultado ao provedor externo como o Instituto Oswaldo Cruz e o Instituto Adolfo Lutz o aceite ou não do acordo;
4.1.3.13. Os custos da caracterização ou tipificação serão cobertos pelo laboratório que encaminhou a cepa.
¶ A. Detecção da Reposta Imune - Ensaio Imunoenzimático (ELISA)
Materiais
- Luvas para procedimentos;
- Pipetas de vidro graduadas ou descartáveis;
- Provetas graduadas;
- Béqueres;
- Erlenmeyers;
- Ponteiras descartáveis
- Reservatórios para soluções (cubetas);
- Papel absorvente;
- Selador ou tampa para placas de ELISA;
- Caneta para identificação de vidraria; e
- Cubas para descarte de materiais resistente à autoclavação.
Equipamentos e instrumentos
- Geladeira;
- Freezer;
- Estufa (opcional);
- Termômetros;
- Micropipetas monocanal e multicanal de volumes reguláveis;
- Pipetador automático ou manual;
- Leitora de ELISA;
- Cronômetros;
- Agitador de tubos tipo vórtex (opcional);
- Agitador de microplacas (opcional);
- Lavadora de microplacas (opcional); e
- Autoclave.
Insumos
- Kits de ELISA para a detecção de anticorpos para salmonela.
Soluções
- No preparo das soluções deve ser utilizado somente os reagentes fornecidos pelo fabricante, ou aqueles por ele indicados;
- Conjugados, substratos e solução de parada deverão ser utilizados obedecendo-se as condições do fabricante;
- No preparo da solução de lavagem deve-se assegurar que não existem cristais precipitados na solução; e
- Diluir as soluções utilizando água ultrapura, destilada, deionizada ou purificada, conforme instruções do fabricante e homogeneizar bem.
Realização do ensaio
- Para realização dos ensaios de ELISA devem ser consideradas as orientações do fabricante do kit de diagnóstico utilizado. Atentar para ocorrência de atualização na bula do kit, principalmente em mudanças de lote;
- A ordem de execução das etapas do ensaio, duração, volumes utilizados e temperatura de incubação variam de acordo com fabricante do kit utilizado;
- Homogeneizar gentilmente todos reagentes e amostras antes do uso;
- Utilizar ponteiras distintas para cada controle e amostra de soro;
- Homogeneizar as placas tocando-as na lateral ou utilizando um agitador de placas;
- Nas etapas de incubação, as placas devem ser seladas para se evitar evaporação e incubadas na temperatura estabelecida pela bula do fabricante do kit;
- As placas devem ser lavadas com a solução indicada pelo kit. Após a última lavagem remover resíduos em um material absorvente. Deixar as placas secas o mínimo de tempo possível entre a lavagem e adição do próximo reagente; e
- Decorridas todas as etapas do teste, realizar a leitura da absorbância na leitora de ELISA utilizando filtro com comprimento de onda indicado nas instruções do fabricante.
Critérios de aceitação do Ensaio
O resultado do ensaio será considerado válido somente se as Densidades óticas (DOs) dos soros controles e os demais parâmetros calculados a partir delas estiverem dentro dos limites aceitáveis e determinados pelo fabricante. Caso contrário, o ensaio deve ser repetido.
Interpretação dos resultados
De acordo com as DOs obtidas, consideram-se as amostras como POSITIVAS ou NEGATIVAS ou de acordo com o preconizado com o fabricante do insumo (kit de diagnóstico).
Emissão dos resultados
a)Os resultados deverão ser emitidos e expressos como POSITIVO ou NEGATIVO ou de acordo com o preconizado com o fabricante do insumo (kit de diagnóstico).
b)Expressar a quantidade de amostras de soro positivas dentre o total de analisadas.
Descarte de Amostras e Resíduos
a)Antes da realização do descarte de amostras deverão ser observados os prazos mínimos estabelecidos no item “Retenção de itens de ensaio”;
b)Os materiais descartados devem ser separados adequadamente entre resíduos químicos e biológicos;
c)Todo o resíduo biológico do ensaio deve ser submetido ao processo de autoclavação apropriado. A efetividade da esterilização deve estar comprovada em procedimentos próprios do laboratório e devem ser utilizados controles físicos, químicos e biológicos para o monitoramento do processo; e
d)O laboratório deve assegurar a biossegurança dos resíduos gerados, e seguir as legislações ambientais vigentes durante todo o processo do descarte.
Retenção de itens de ensaio
Amostras podem ser descartadas após um período mínimo de 30 dias da realização das análises, registrando-se em formulários próprios e conferidas antes do descarte.
¶ B. Detecção da Resposta Imune - Soroaglutinação rápida em placa (SAR)
Materiais
- Luvas descartáveis;
- Placa de vidro (ou outro material rígido) quadriculada;
- Ponteiras descartáveis para micropipetas de volume apropriado;
- Misturador simples ou múltiplo para homogeneizar; e
- Recipientes para descarte.
Equipamentos e instrumentos
- Micropipeta de volume regulável;
- Banho-maria;
- Fonte de luz;
- Cronômetro;
- Microcentrífuga; e
- Autoclave.
Insumos
- Antígeno corado para aglutinação rápida de Salmonella Pullorum (SAR);
- Soro controle POSITIVO para salmonela; e
- Soro controle NEGATIVO para salmonela.
Soluções
Não aplicável.
Realização do ensaio
Preparo das amostras
- Este ensaio não pode ser realizado com amostras que foram congeladas; e
- Deixar as amostras atingirem temperatura ambiente (18 a 25°C) ou a temperatura indicada pela bula do fabricante do Antígeno antes de realizar o ensaio.
Preparo dos reagentes
Os antígenos devem estar na temperatura ambiente (18 a 25°C). Homogeneizar o frasco contendo o antígeno constantemente durante a realização do ensaio para evitar precipitação.
Soroaglutinação Rápida – SAR
- Realizar o ensaio na temperatura indicada pelo fabricante;
- Homogeneizar suavemente o frasco contendo o antígeno durante a realização do ensaio para evitar precipitação;
- Depositar o volume indicado pelo fabricante do antígeno no centro de um quadradinho da placa limpa e desprezar a ponteira. Caso a bula do produto não indique o volume exato a utilizar, o fabricante deverá ser contatado;
- Depositar mesma quantidade do soro a ser testado sobre a gota do antígeno e homogeneizar ambas com auxílio de ponteira, bastão ou homogeneizador múltiplo, formando um círculo de aproximadamente 1,5 cm de diâmetro;
- Agitar suavemente a placa, fazendo movimentos circulares;
- Observar a formação de grumos colocando a placa contra a fonte luminosa e fundo branco após transcorrido o tempo especificado pelo fabricante; e
- Em paralelo às amostras, devem sempre ser incluídos:
- Soro controle POSITIVO; e
- Soro controle NEGATIVO.
Critérios de aceitação do ensaio
O ensaio será válido quando:
- O controle POSITIVO apresentar formação de grumos sob as condições especificadas para o ensaio pelo fabricante do insumo; e
- O controle NEGATIVO não apresentar nenhuma formação de grumos.
Interpretação dos resultados
- Considerar a amostra positiva quando houver qualquer grau de formação de grumos, dentro do tempo preconizado pelo fabricante, ainda que com menor intensidade que o controle POSITIVO; e
- Considerar a amostra negativa quando não houver qualquer grau de formação de grumos.
Emissão dos resultados
- Os resultados deverão ser emitidos e expressos como POSITIVO ou “NEGATIVO”; e
- Expressar a quantidade de amostras de soro positivas dentre o total de analisadas.
Descarte das amostras e Resíduos
- Antes da realização do descarte de amostras e produtos de ensaio deverão ser observados os prazos mínimos estabelecidos no item “Retenção de Itens de Ensaio”.
- Os materiais descartados devem ser separados adequadamente entre resíduos químicos e biológicos;
- Todo o resíduo biológico do ensaio deve ser submetido ao processo de autoclavação apropriado. A efetividade da esterilização deve estar comprovada em procedimentos próprios do laboratório e devem ser utilizados controles físicos, químicos e biológicos para o monitoramento do processo; e
- O laboratório deve assegurar a biossegurança dos resíduos gerados, e seguir as legislações ambientais vigentes durante todo o processo do descarte.
Retenção de Itens de Ensaio
Após um período mínimo de 30 dias da realização das análises, as amostras poderão ser descartadas, registrando-se em formulários próprios e conferidas antes do descarte.
¶ C. Detecção da Resposta Imune - Soroaglutinação Lenta em Tubos -SAL
Materiais
- Luvas descartáveis;
- Tubos de plástico ou vidro transparentes e com tampa, de capacidade adequada ou;
- Microplacas com fundo em U", de capacidade adequada;
- Estante para os tubos;
- Ponteiras; e
- Recipiente para descarte de ponteiras e tubos.
Equipamentos e instrumentos
- Micropipetas de volume apropriado ou pipeta graduada que dispense os volumes necessários;
- Fonte de Luz;
- Estufa; e
- Autoclave.
Insumos
- Antígeno para soroaglutinação lenta de Salmonella Pullorum/Gallinarum -SAL;
- Soro controle POSITIVO para salmonela; e
- Soro controle NEGATIVO para salmonela.
Soluções
Não aplicável
Realização do ensaio
Preparo das amostras
Caso indicado pelo fabricante, inativar as amostras a 56 °C por 30 minutos antes da realização do ensaio.
Preparo dos reagentes
Antes e durante a realização do ensaio, homogeneizar bem o frasco de antígeno para SAL de salmonela, observando se não há nenhum depósito no fundo.
Soroaglutinação Lenta em Tubos -SAL
a)As etapas de realização do ensaio podem variar de acordo com o fabricante, devendo o analista sempre verificar a bula do antígeno e seguir as recomendações por ela fornecidas;
b)Identificar um tubo ou um poço para cada soro a ser testado e um para cada controle;
c)Distribuir volume especificado pelo fabricante do antígeno em cada tubo ou poço, utilizando a pipeta graduada ou a micropipeta;
d)Adicionar volume especificado pelo fabricante de cada soro a ser analisado em seu respectivo tubo ou poço, assim como os controles POSITIVO e NEGATIVO, utilizando a micropipeta;
e) Homogeneizar para que haja mistura total da amostra/controle com o antígeno;
f)Adicionar ao ensaio um tubo ou um poço contendo apenas o antígeno, como forma de controle de possível auto aglutinação;
g)Incubar em estufa a 37°C ± 1 °C por 16 a 24 horas ou de acordo com instrução do fabricante;
h)Proceder com a leitura, com luz indireta, contra fundo escuro.
Critérios de aceitação do ensaio
- Controle POSITIVO apresenta sobrenadante límpido com depósito granular. Sob agitação leve, o precipitado forma grumos;
- Controle NEGATIVO apresenta sobrenadante turvo, com ausência de grumos quando da agitação leve; e
- Controle de antígeno apresenta sobrenadante turvo, com ausência de grumos quando da agitação leve, semelhante ao controle NEGATIVO.
Interpretação dos resultados
São consideradas positivas as amostras que apresentarem características de formação de grumos semelhante ao controle POSITIVO, ainda que em menor dimensão e quantidade.
Emissão dos resultados
- Os resultados deverão ser emitidos e expressos como “POSITIVO” ou “NEGATIVO”; e
- Expressar a quantidade de amostras de soro positivas dentre o total de analisadas.
Descarte das amostras e Resíduos
- Antes da realização do descarte de amostras e produtos de ensaio deverão ser observados os prazos mínimos estabelecidos no item “Retenção de Itens de Ensaio;
- Todo o material utilizado na realização do ensaio deve ser submetido ao processo de autoclavação apropriado. A efetividade da esterilização deve estar comprovada em procedimentos próprios do laboratório e devem ser utilizados controles físicos, químicos e biológicos para o monitoramento do processo;
- Os materiais descartados devem ser separados adequadamente entre resíduos químicos e biológicos; e
- O laboratório deve assegurar a biossegurança dos resíduos gerados, e seguir as legislações ambientais vigentes durante todo o processo do descarte.
Retenção de itens de ensaio
Após um período mínimo de 30 dias da realização das análises, as amostras poderão ser descartadas, registrando-se em formulários próprios e conferidas antes do descarte.
¶ D. Identificação do Agente - Isolamento de Salmonela
Materiais
- Luvas para procedimento;
- Alças bacteriológicas descartáveis ou flambáveis;
- Agulhas bacteriológicas descartáveis ou flambáveis;
- Placas de Petri com meio de cultura de diâmetro mínimo de 9 cm;
- Placas de Petri com meio de cultura de diâmetro mínimo de 6 cm (opcional para o MSRV);
- Pipetas estéreis de volumes variados (opcional);
- Seringas descartáveis de volumes variados (opcional);
- Micropipetas de volumes variados;
- Pinça ou pazinha estéril;
- Tesoura estéril (opcional);
- Tubos;
- Conta-gotas;
- Suporte para placas;
- Suporte para tubos; e
- Cubas para descarte com líquido desinfetante (opcional).
Equipamentos e instrumentos
- Cabine de Segurança Biológica classe II A2 (preferencial) ou bancada com bico de Bunsen;
- Esterilizador de alças bacteriológicas (opcional);
- Estufas;
- Geladeira;
- Balança semi-analítica (opcional);
- Agitador tipo vórtex (opcional);
- Homogeneizador para laboratórios de microbiologia (opcional); e
- Autoclave.
Insumos
- Caldo BHI;
- Caldo Tetrationato com Novobiocina a 4%;
- Caldo Rappaport Vassiliadis;
- Meio semissólido modificado Rappaport-Vassiliadis (MRSV);
- Ágar MacConkey;
- Ágar Hektoen;
- Ágar Xilose Lisina Deoxicolato (XLD) ou ágar verde brilhante (BPLS);
- Ágar Rambach;
- Ágar tríplice açúcar ferro (TSI);
- Ágar lisina ferro (LIA);
- Meio SIM;
- Caldo Uréia;
- Caldo fermentação de carboidratos - vermelho de fenol;
- Caldo fermentação de carboidratos - vermelho de fenol em frasco com tubo de Duhran;
- Caldo base Moeller;
- Caldo base Moeller ornitina;
- Caldo base Moeller lisina;
- Ágar nutriente;
- Ágar Stock;
- Reativos de Kovacs ou Ehrlich;
- Óleo mineral estéril; e
- Controle POSITIVO (cepa de referência dos sorovares de controle do PNSA ou de um sorovar de controle de Salmonella spp., podendo ser distinta dos sorovares de controle do PNSA ou de um sorovar de controle do PNSA).
Soluções
- Água Peptonada 1% pH 7,2 + 0,2;
- Solução de iodo-iodeto (iodo 20%, iodeto 25%);
- Solução de Lactose 10%;
- Solução de Sacarose 10%;
- Solução de Dulcitol 5%;
- Solução de Maltose; e
- Solução de Glicose 10%.
Realização do ensaio
Considerações gerais
- Todas as etapas devem ser realizadas em cabine de segurança biológica ou no raio de esterilidade do bico de Bunsen;
- Deve ser utilizado um controle POSITIVO (cepa de Salmonella spp ou um sorovar de controle do PNSA) em todas as etapas do isolamento;
- Inicialmente deve ser escolhido um dos métodos de triagem (QUADRO 1) de acordo com o tipo da amostra. As colônias encontradas como suspeitas de salmonela devem seguir para a etapa de Purificação;
- O laboratório pode optar por realizar a Triagem por qPCR para Salmonella spp. ou por BAX® antes da realização do Isolamento;
- Após a realização do Isolamento deve ser feita a Caracterização da cultura isolada, através da Caracterização Antigênica ou Tipificação molecular (microarranjo de DNA) ou qPCR específico para os sorovares do PNSA. No caso de ser utilizado um dos métodos moleculares, é possível abreviar as etapas do Isolamento desde que a verificação de desempenho realizada pelo laboratório tenha contemplado essa possibilidade conforme. Todas as etapas estão indicadas no ANEXO – Fluxograma de processamento de amostras não sorológicas de salmonela.
Triagem em meio seletivo diferencial
Pré-Enriquecimento de material fecal
Homogeneizar a amostra e inocular:
- 2 mL ou 2 g da amostra em 20 mL de caldo BHI ou 2 mL ou 2 g da amostra em 20 mL água peptonada a 1%; e
- Incubar em estufa a 37 °C ± 1°C por 18-24 horas.
Nota: Sempre que houver qualquer impedimento à continuação imediata dos procedimentos do método de Isolamento, amostras enriquecidas podem ser armazenadas sob refrigeração (entre 2 e 8°C) por até 72 horas após a incubação.
Enriquecimento de material fecal
- Adicionar 400 µL de solução de iodo-iodeto em cada um dos tubos de caldo Tetrationato com Novobiocina a 4%, no momento do uso;
- Homogeneizar a amostra a partir do pre-enriqueciemento e inocular:
- 2 mL da amostra em 20 mL de Caldo Tetrationato;
- 0,2 mL da amostra em 20 mL de Caldo Rappaport;
- Incubar o
scaldosTetrationato a 37°C ± 1 °C por 18-24 horas; - Incubar o caldo Rappaport a 41,5°C ± 1 °C por 18-24 horas;
- Ao final do procedimento inocular uma cepa de controle POSITIVO (cepa de referência de Salmonella spp ou de um sorovar de controle do PNSA) nos caldos Tetrationato e Rappaport; e
- sempre que houver qualquer impedimento à continuação imediata dos procedimentos do método de Isolamento, amostras enriquecidas podem ser armazenadas sob refrigeração (entre 2 e 8°C) por até 72 horas após a incubação.
Pre-enriquecimento de material ambiental e suabes
- Adicionar aproximadamente 20 a 50 mL de água peptonada 1%, ou na proporção 1:10 em quantidade suficiente para cobrir a amostra com o líquido;
- Incubar em estufa a 37 °C ± 1°C por 18-24 horas; e
- Sempre que houver qualquer impedimento à continuação imediata dos procedimentos do método de Isolamento, amostras enriquecidas podem ser armazenadas sob refrigeração (entre 2 e 8°C) por até 72 horas após a incubação.
Enriquecimento de material ambiental e suabes
- Adicionar 400 µL de solução de iodo-iodeto em cada um dos tubos de caldo Tetrationato com Novobiocina a 4%, no momento do uso;
- Homogeneizar a amostra pré-enriquecida e inocular:
- Adicionar 2 mL em 20 mL de Caldo Tetrationato;
- Adicionar 0,2 mL em 20 mL de Caldo Rappaport;
- Incubar o caldo Tetrationato a 37°C ± 1 °C por 18-24 horas;
- Incubar o caldo Rappaport a 41,5°C ± 1 °C por 18-24 horas;
- Ao final do procedimento inocular o controle POSITIVO (cepa de referência de Salmonella spp ou de um sorovar de controle do PNSA) nos caldos Tetrationato e Rappaport; e
- Sempre que houver qualquer impedimento à continuação imediata dos procedimentos do método de Isolamento, amostras enriquecidas podem ser armazenadas sob refrigeração (entre 2 e 8°C) por até 72 horas após a incubação.
Enriquecimento de órgãos e tecidos
- Adicionar 400 µL de solução de iodo-iodeto em cada um dos tubos de caldo Tetrationato com Novobiocina a 4%, no momento do uso;
- Triturar/macerar/homogeneizar a amostra e inocular:
- Adicionar 2 mL ou 2 g em 20 mL de caldo BHI;
- Adicionar 2 mL ou 2 g em 20 mL de Caldo Tetrationato;
- Adicionar 0,2 mL ou 0,2 g em 20 mL de Caldo Rappaport;
- Incubar o caldo BHI a 37 °C ± 1 °C por 18-24 h;
- Incubar o
scaldosTetrationato a 37°C ± 1 °C por 18-24 horas - Incubar o caldo Rappaport a 41,5°C ± 1 °C por 18-24 horas;
- Ao final do procedimento inocular o controle POSITIVO (cepa de referência de Salmonella spp ou de um sorovar de controle do PNSA) nos caldos BHI, Tetrationato e Rappaport; e
- Sempre que houver qualquer impedimento à continuação imediata dos procedimentos do método de Isolamento, amostras enriquecidas podem ser armazenadas sob refrigeração (entre 2 e 8°C) por até 72 horas após a incubação.
Plaqueamento seletivo diferencial para material fecal, ambiental, suabes, órgãos e tecidos
- Secar as placas antes do uso;
- As placas devem ser mantidas, durante todo o tempo de armazenamento, secagem e incubação com a superfície de inoculação do ágar voltado para baixo;
- Agitar o tubo contendo o material enriquecido;
- Retirar uma alíquota do inóculo do caldo de enriquecimento;
- Plaquear cada tubo de caldo de enriquecimento em pelo menos um meio de cultura com alta seletividade (ágar XLD ou BPLS) e pelo menos um meio de média seletividade (ágar Hektoen ou ágar MacConkey). Pode ser realizada uma única alçada para cada caldo a ser plaqueado.
- Adicionalmente o laboratório pede incluir nesta fase o Ágar Rambach ou outro ágar cromógeno. Para isto o laboratório deverá realizar a verificação de desempenho do mesmo.
- Esgotar o inóculo na extremidade do ágar e estriar a partir deste ponto. As estrias devem ser próximas e deve-se aproveitar toda a extensão da placa (FIGURA 1);
- Inocular uma placa de cada ágar utilizado com as culturas de controle POSITIVO de salmonela provenientes dos caldos BHI, Tetrationato e Rappaport enriquecidos na etapa de enriquecimento;
- Incubar as placas à temperatura de 37 °C ± 1 °C por 18-24 horas;
- Caso haja necessidade de divisão de placas entre duas alíquotas, elas deverão pertencer à mesma amostra. Para que haja divisão, a placa deverá ter, no mínimo, 9 cm de diâmetro; e
- Em nenhuma hipótese deve-se estriar uma amostra e um controle POSITIVO na mesma placa.
FIGURA 1. Técnica de semeadura por esgotamento em ágar

QUADRO 1. Caldos e ágares utilizados para incubação por material
| Método de Triagem | Amostras | Pré enriquecimento | Enriquecimento | Ágar | ||||
|---|---|---|---|---|---|---|---|---|
| Água peptonada | Caldo BHI | Tetrationato | Rappaport | BPLS ou XLD | Mac ou Hek | MSRV | ||
| 37°C | 37°C | 37°C | 41,5°C | 37°C | 37°C | 41,5°C | ||
| Meio seletivo diferencial | Material Fecal | X | X | X | X | X | ||
| Material ambiental e suabes | X | X | X | X | X | |||
| Órgãos e tecidos | X | X | X | X | X | |||
| Controle POSITIVO | X | X | X | X | X | |||
| Meio MSRV | Material Fecal | X | X | |||||
| Material Ambiental e suabes | X | X | ||||||
| Controle POSITIVO | X | X | ||||||
Mac: MacConkey; Hek: Hektoen. (Fonte: LFDA-SP)
Leitura das placas
- A leitura deverá ser realizada, primeiramente, verificando-se a efetividade do controle POSITIVO utilizado, que deverá ter crescimento bem-sucedido;
- Quando não houver crescimento nas primeiras 24 horas, incubar por mais 24 horas em estufa a 37 ± 1 °C;
- Selecionar, no mínimo, 3 colônias com características suspeitas de salmonela abrangendo todas as placas. Caso haja diferenças morfológicas entre as colônias suspeitas numa mesma placa, deve-se selecionar uma colônia de cada morfologia e realizar o bioquimismo; e
- Antes do bioquimismo o laboratório pode optar por realizar a Purificação em ágar Rambach ou XLD conforme item específico e realizar a leitura conforme aspecto das colônias de salmonela típicas, conforme indicado no QUADRO 2.
QUADRO 2. Aspecto das colônias de salmonela típicas em meios de cultura seletivos
| Meio de cultura | Aspecto das colônias típicas | |
|---|---|---|
| Ágar MacConkey | Transparente ou incolor |
 |
| Ágar Hektoen | Verdes azuladas podendo apresentar um centro negro |
 |
| Ágar BPLS | Cor rosada, entre translúcida ou ligeiramente opaca |
 |
| Ágar XLD | Cor-de-rosa (colônias H2S NEGATIVO) e avermelhadas com centro negro (colônias H2S POSITIVO) |
 |
| Ágar Rambach | Cor rosa claro a rosa escuro |
 |
| Transparentes e amareladas |
|
|
Fonte: fotos de LFDA-SP; adaptado de DUARTE, S. C. et al, 2016 e ISO 6579-1:2017.
Purificação em ágar Rambach ou XLD (Opcional)
- As colônias suspeitas obtidas nos ágares de triagem podem passar pela etapa de purificação a fim de dar continuidade ao método de isolamento;
- Inocular uma alçada da cultura em ágar XLD ou Rambach de modo a obter colônias bem isoladas, estriando o inóculo em três direções diferentes. Utilizar uma alça bacteriológica estéril a cada mudança de direção do estriamento sem recarregá-la com a cultura bacteriana;
- Adicionalmente o laboratório pede incluir nesta fase outro ágar cromógeno. Para isto o laboratório deverá realizar a verificação de desempenho do mesmo.
- Ao final do procedimento, inocular uma placa com o controle POSITIVO (cepa de referência de Salmonella spp ou de um sorovar de controle do PNSA); e
- Incubar a 37 °C ± 1 °C por 18-24 horas.
Leitura das placas
- A leitura deverá ser realizada, primeiramente, verificando-se a efetividade do controle POSITIVO utilizado, que deverá ter crescimento bem-sucedido;
- Colônias típicas de salmonela em ágar Rambach se apresentam com variações da coloração rosa, sendo que alguns sorovares podem se apresentar transparentes e mais amareladas (QUADRO 2);
- Colônias típicas de salmonela em ágar XLD se apresentam com variações da coloração rosa (colônias H2S NEGATIVO) e avermelhadas com centro negro (colônias H2S POSITIVO) (QUADRO 2);
- Quando não houver crescimento nas primeiras 24 horas, incubar por mais 24 horas em estufa a 37 ± 1 °C;
- Selecionar, no mínimo 1 colônia de cada placa com características suspeitas de salmonela e realizar o bioquimismo ou o microarranjo de DNA. Caso haja diferenças morfológicas entre as colônias suspeitas numa mesma placa, deve-se selecionar uma colônia de cada morfologia;
- Caso não haja crescimento de colônias suspeitas após esse procedimento, a amostra pode ser considerada negativa para Salmonella spp; e
- Sempre que houver qualquer impedimento à continuação imediata dos procedimentos do método de Isolamento, deve-se inocular as colônias selecionadas em ágar nutriente inclinado, incubar a 37°C ± 1 °C por 18-24 horas e manter em temperatura ambiente (18 a 25°C), até que seja possível o retorno das atividades.
Triagem de material fecal e ambiental em meio MSRV (opcional)
Pré-enriquecimento de material fecal
- Adicionar 2 g em 20 mL de água peptonada 1%;
- Incubar em estufa a 37 °C ± 1°C por 18-24 horas; e
- Após incubação, amostras pré-enriquecidas podem ser armazenadas sob refrigeração (entre 2 e 8°C) por até 72 horas antes da etapa de enriquecimento.
Pré-enriquecimento de materiais ambientais e suabes
- Adicionar aproximadamente 20 a 50 mL de água peptonada 1%, ou na proporção 1:10 em quantidade suficiente para cobrir o material com o líquido;
- Incubar em estufa a 37 °C ± 1°C por 18-24 horas; e
- Após incubação, amostras pré-enriquecidas podem ser armazenadas sob refrigeração (entre 2 e 8°C) por até 72 horas antes da etapa de enriquecimento.
Inoculação em meio MSRV
- Homogeneizar a amostra pré-enriquecida e coletar 100µL;
- Aplicar o volume em um ponto do meio MSRV, podendo ser inoculadas até três alíquotas da mesma amostra na mesma placa, dispostas em pontos equidistantes. As gotas não poderão se espalhar pela placa (Figura 2);
- Ao final do procedimento, inocular um controle POSITIVO (cepa de referência de Salmonella spp ou de um sorovar de controle do PNSA) e um controle NEGATIVO (água peptonada); e
- Incubar a 41,5°C ± 1 °C por 18-24 horas, mantendo a superfície do ágar voltada para cima.
FIGURA 2. Inoculação em meio MSRV (até três amostras por placa)

Leitura das placas
- A leitura deverá ser realizada, primeiramente, verificando-se a efetividade do controle POSITIVO, que deverá ter crescimento bem-sucedido, e a ausência de crescimento do controle NEGATIVO;
- Havendo formação de halo esbranquiçado, a amostra é suspeita de salmonela. (Quadro 3);
- Coletar uma alçada do crescimento bacteriano suspeito a partir da borda de cada halo formado no meio MSRV para a etapa de purificação em ágar Rambach ou XLD;
- Amostras para as quais não houver formação de halo no meio MSRV deverão permanecer em estufa a 41,5°C ± 1 °C por mais 24 horas. Caso não haja formação de halo esbranquiçado, a amostra é negativa para Salmonella spp;
- Sempre que houver qualquer impedimento à continuação imediata dos procedimentos do método de Isolamento, as placas de MSRV inoculadas podem ser armazenadas sob refrigeração (entre 2 e 8°C) por até 72 horas após a incubação.
QUADRO 3. Aspecto das colônias de salmonela típicas em meio MSRV
| Meio de cultura | Aspecto das colônias típicas |
|---|---|
| Meio MSRV |
Colônias positivas: formação de halo esbranquiçado 
A: crescimento característico (amostra suspeita); B e C: crescimento não característico (amostras negativas) |
Purificação em ágar Rambach ou XLD
- As colônias suspeitas obtidas do método de triagem MSRV devem passar pela etapa de purificação a fim de dar continuidade ao método de isolamento;
- A purificação é opcional caso seja realizada a técnica de microarranjo de DNA (item 3.7);
- Inocular uma alçada da cultura em ágar XLD ou Rambach de modo a obter colônias bem isoladas, estriando o inóculo em três direções diferentes. Utilizar uma alça bacteriológica estéril a cada mudança de direção do estriamento sem recarregá-la com a cultura bacteriana (FIGURA 1);
- Ao final do procedimento, inocular uma placa com o controle POSITIVO (cepa de referência de Salmonella spp ou de um sorovar de controle do PNSA); e
- Incubar a 37 °C ± 1 °C por 18-24 horas.
Leitura das placas
- A leitura deverá ser realizada, primeiramente, verificando-se a efetividade do controle POSITIVO utilizado, que deverá ter crescimento bem-sucedido;
- Colônias típicas de salmonela em ágar Rambach se apresentam com variações da coloração rosa, sendo que alguns sorovares podem se apresentar transparentes e mais amareladas (QUADRO 2.);
- Colônias típicas de salmonela em ágar XLD se apresentam com variações da coloração rosa (colônias H2S NEGATIVO) e avermelhadas com centro negro (colônias H2S POSITIVO) (QUADRO 2);
- Quando não houver crescimento nas primeiras 24 horas, incubar por mais 24 horas em estufa a 37 ± 1 °C;
- Selecionar, no mínimo 1 colônia de cada placa com características suspeitas de salmonela e realizar o bioquimismo, o microarranjo de DNA ou o qPCR para Salmonela.
- Caso o qPCR seja positivo é obrigatória a realização das técnicas moleculares para a identificação dos sorovares do PNSA.
- Caso haja diferenças morfológicas entre as colônias suspeitas numa mesma placa, deve-se selecionar uma colônia de cada morfologia;
- Caso não haja crescimento de colônias suspeitas após esse procedimento, a amostra pode ser considerada negativa para Salmonella spp; e
- Sempre que houver qualquer impedimento à continuação imediata dos procedimentos do método de Isolamento, deve-se inocular as colônias selecionadas em ágar nutriente inclinado, incubar a 37°C ± 1 °C por 18-24 horas e manter em temperatura ambiente (18 a 25°C), até que seja possível o retorno das atividades.
Série bioquímica preliminar
- As colônias com morfologia suspeita de salmonela devem ser semeadas nos meios de bioquimismo preliminar: Ágar TSI, Ágar LIA, Meio SIM e Caldo Ureia. Utilizar colônias isoladas para o teste. Pode ser feita uma só alçada por colônia testada;
- Ao final do procedimento, inocular um tubo de cada meio utilizado com o controle POSITIVO (cepa de referência de Salmonella spp ou de um sorovar de controle do PNSA);
- As colônias bacterianas que apresentarem reações compatíveis com o gênero Salmonella com motilidade positiva podem ou não passar por bioquimismo complementar, a critério do laboratório;
- As colônias bacterianas que apresentarem motilidade negativa (imóveis) deverão seguir obrigatoriamente para a etapa do bioquimismo complementar; e
- O laboratório pode optar por não realizar as etapas de bioquimismo preliminar e/ou complementar da colônia caso realize técnicas moleculares para a tipificação do sorovar.
Ágar TSI e LIA
- Inocular a colônia bacteriana com auxílio de agulha bacteriológica por picada no centro do ágar até a metade da profundidade e estriar a rampa; e
- Incubar os tubos inoculados à temperatura de 37 °C ± 1°C por 18-24 horas.
Meio SIM
- Inocular a colônia bacteriana com auxílio de agulha bacteriológica por picada no centro do ágar até a metade da profundidade. Retirar a agulha na mesma direção;
- Incubar os tubos inoculados à temperatura de 37 °C ± 1 °C por 18-24 horas; e
- Após a leitura da motilidade e da produção de H2S, adicionar três gotas da solução reveladora (reativos de Kovac ou Ehrlich) para a prova do indol.
Caldo Ureia
- Inocular a colônia bacteriana com auxílio de agulha ou alça bacteriológica; e
- Incubar os tubos inoculados à temperatura de 37 °C ± 1 °C por 18-24 horas.
Leitura do bioquimismo preliminar
A identificação bioquímica preliminar no gênero Salmonella segue o disposto no QUADRO 4.
QUADRO 4. Identificação bioquímica preliminar do gênero Salmonella
| Comportamento bioquímico | Salmonella Pullorum | Salmonella Gallinarum | Salmonella sp sub-espécie I | Salmonella sp sub-espécies IIIa e IIIb | |
|---|---|---|---|---|---|
|
TSI 24 horas |
Base | A gás +/- | A gás - | A gás + | A gás + |
| Bisel | V | V | V | V ou A | |
| H2S | +/- | + | + | + | |
|
LIA 24 horas |
Base | P | P | P | P |
| Bisel | P | P | P | P | |
| H2S | +/- | + | + | + | |
|
SIM 24 horas |
Motilidade | - | - | + | + |
| Indol | - | - | - | - | |
| H2S | +/- | + | + | + | |
| Urease | - | - | - | - | |
Salmonella sp subespécie I – S. Typhimurium e S. Enteritidis (entre outras);
Salmonella sp subespécie III a e III b - Antigo grupo Arizona;
A – Amarelo (ácido); V – vermelho (alcalino); P – púrpura (alcalino).
Fonte: Adaptado de DUARTE, S. C. et al, 2016.
Série bioquímica complementar
- Esta etapa é obrigatória para colônias suspeitas de salmonela com motilidade negativa (imóveis);
- A realização desta etapa não é obrigatória para colônias que se apresentarem com motilidade positiva no meio SIM (móveis);
- O inóculo a ser utilizado na série complementar deverá ser retirado do ágar TSI do teste anterior (Bioquimismo Preliminar);
- Ao final do procedimento, inocular um tubo de cada meio utilizado com o controle POSITIVO (cepa de referência de Salmonella spp ou de um sorovar de controle do PNSA);
- As colônias bacterianas que apresentarem reações compatíveis com o gênero Salmonella na caracterização bioquímica deverão ser submetidas à caracterização antigênica, tipificação por microarranjo de DNA ou qPCR para salmonella spp; e
- Caso o qPCR seja positivo para salmonella spp é obrigatória a realização das técnicas moleculares para a identificação dos sorovares do PNSA.
Série de açúcares
- Para cada colônia a ser testada, separar seis tubos contendo caldo fermentação, sendo um deles com tubo de Duhran. Identificá-los com os nomes dos açúcares a serem testados na seguinte ordem: Lactose, Sacarose, Dulcitol, Maltose e Glicose (caldo contendo o tubo Duhran);
- Adicionar 500 µL da solução de cada açúcar nos tubos previamente identificados. A solução de Dulcitol deve ser dissolvida em banho-maria antes da adição ao caldo, devido à precipitação de cristais. A adição dos açúcares ao caldo fermentação deve ocorrer no momento da realização do procedimento;
- Inocular a colônia bacteriana lavando-se a alça sequencialmente nos caldos, na seguinte ordem: Lactose, Sacarose, Dulcitol, Manitol, Maltose e Glicose (tubo contendo o tubo Duhran);
- Incubar os tubos inoculados à temperatura de 37 ± 1°C por 18-24 horas; e
- Em caso de resultado NEGATIVO nas primeiras 24 horas, incubar novamente a 37 °C ± 1 °C por 18-24 horas.
Série de aminoácidos
- Deve-se utilizar um tubo contendo apenas o meio base Moeller, sem adição de aminoácidos, para controle do teste;
- Inocular a colônia bacteriana lavando-se a alça sequencialmente nos caldos ornitina e lisina, e no caldo de controle do teste;
- Ao final do procedimento, vedar a superfície dos caldos com algumas gotas de óleo mineral;
- Incubar os tubos inoculados à temperatura de 37 ± 1 °C por 18-24 horas; e
- Em caso de resultado NEGATIVO nas primeiras 24 horas, incubar novamente a 37 °C ± 1 °C por 18-24 horas.
Leitura do bioquimismo complementar
A identificação Bioquímica complementar do gênero Salmonella segue o disposto no QUADRO 5.
QUADRO 5. Identificação bioquímica complementar do gênero Salmonella
| Comportamento bioquímico | Salmonella sp sub-espécie I | Salmonella Pullorum | Salmonella Gallinarum | Salmonella sp sub-espécies IIIa e IIIb |
|---|---|---|---|---|
| Lactose | - | - | - | d |
| Sacarose | - | - | - | - |
| Dulcitol | + | - | + (*) | - |
| Maltose | + | - (**) | + | + |
| Glicose produção de ácido | + | + | + | + |
| Glicose produção de gás | + | d | - | + |
| Ornitina descarboxilase | + | +(*) | - | + |
| Lisina descarboxilase | + | + | + | + |
Salmonella sp subespécie I – S. Typhimurium e S. Enteritidis (entre outras);
Salmonella sp subespécie III a e III b - Antigo grupo Arizona;
(+) - 90-100% de cepas são positivas;
(-) - 90-100% de cepas são negativas;
(d) – Diferentes tipos;
(*) – Ocasionalmente negativa;
(**) – ou tardiamente positiva.
Fonte: adaptado de DUARTE, S. C. et al, 2016.
Critérios de Aceitação do Ensaio
- A leitura do controle POSITIVO em todas as etapas do isolamento deve ser satisfatória, apresentando resultados compatíveis com cultura suspeita para salmonela;
- O controle NEGATIVO deve ser ausente de crescimento em todas as etapas; e
- Em caso de crescimento insatisfatório para qualquer um dos controles, a etapa deverá ser repetida.
Interpretação dos resultados
NEGATIVO
- Não apresentarem crescimento de colônias com caraterísticas morfológicas compatíveis com o gênero Salmonella;
- Não apresentarem bioquimismo compatível com o gênero Salmonella;
- Apresentar resultados negativos nas técnicas moleculares; ou
- Apresentar resultados negativo no anti-soro “O” na caracterização antigênica.
POSITIVO
- Apresentaram resultado Positivo nas técnicas moleculares ou de identificação gênero Salmonella; e
- Apresentar resultado Positivo no anti-soro “O”.
AUSÊNCIA DE CRESCIMENTO BACTERIANO
Amostras de Material Fecal, Material Ambiental e suabes ou Ceco com Tonsilas cecais que não apresentarem crescimento em meios não seletivos ou seletivos, exceto no MSRV.
Emissão dos Resultados
Os resultados deverão ser e expressos como “POSITIVO”, “NEGATIVO” ou “AUSÊNCIA DE CRESCIMENTO BACTERIANO” para cada técnicas de diagnóstico utilizada.
- Deve ser indicado o total de alíquotas negativas, positivas e/ou com ausência de crescimento dentre o total de analisadas, identificando a matriz que obteve cada resultado; e
- No caso de amostras positivas a identificação obtida também deverá ser informada.
Armazenamento de culturas e envio para LFDA-SP
- Quando houver isolamento e caracterização de cepas de salmonela de qualquer sorovar, essas deverão ser armazenadas pelo laboratório e mantidas viáveis, pelo prazo mínimo de 3 anos;
- O laboratório deve seguir orientações da CGAL para enviar um relatório mensal dos sorovares identificados ao LFDA-SP, em via eletrônica. A técnica utilizada para caracterização do sorovar (caracterização antigênica básica, caracterização antigênica ampliada, caracterização antigênica completa, tipificação por microarranjo de DNA ou qPCR específico para os sorovares do PNSA) deve ser informada no documento.
- O laboratório credenciado deve enviar uma replicata ao LFDA-SP das culturas isoladas:
- de granjas de reprodutoras;
- de material genético importado;
- de qualquer origem cujo sorovar identificado seja um dos controlados pelo PNSA, incluindo-se monofásicas e culturas imóveis S. (1,9,12 : - : - ); e
- de qualquer origem cujo sorovar identificado seja Hadar, Infantis ou Virchow; de Salmonella spp., que tenham sido previamente selecionadas pelo MAPA a partir dos relatórios mensais.
- A seleção das culturas para envio obrigatório ao LFDA-SP ocorrerá de acordo com o interesse do MAPA;
- O envio das culturas deve ser feito em frasco de vidro (tipo penicilina) com ágar Stock em bisel; e
- As culturas devem ser enviadas ao LFDA-SP de acordo com os procedimentos descritos no site do MAPA.
Descarte das amostras e resíduos
- Antes da realização do descarte de amostras e produtos de ensaio deverão ser observados os prazos mínimos estabelecidos no item “Retenção de Itens de Ensaio”.
- Os materiais descartados devem ser separados adequadamente entre resíduos químicos e biológicos;
- Todo o resíduo biológico utilizado na realização do ensaio deve ser submetido ao processo de autoclavação apropriado. A efetividade da esterilização deve estar comprovada em procedimentos próprios do laboratório e devem ser utilizados controles físicos, químicos e biológicos para o monitoramento do processo; e
- O laboratório deve assegurar a biossegurança dos resíduos gerados, e seguir as legislações ambientais vigentes durante todo o processo do descarte.
Retenção de itens de ensaio
Amostras para isolamento
Imediatamente após a emissão do laudo, as amostras poderão ser descartadas, registrando-se em formulários próprios e conferidas antes do descarte.
Culturas de salmonela
Após um período mínimo de 03 anos da realização das análises, as culturas poderão ser descartadas, registrando-se em formulários próprios e conferidas antes do descarte.
¶ E. Identificação do agente - Caracterização antigênica por aglutinação
Materiais
- Luvas para procedimento;
- Alças bacteriológicas descartáveis ou flambáveis;
- Placa de vidro quadriculada ou lâmina para sorologia, limpa e desengordurada;
- Micropipetas com ponteiras de volumes variados;
- Pipetas de Pasteur (opcional);
- Placas de Petri estéreis (opcional);
- Tiras de papel filtro de 3 cm estéreis;
- Lâmina ou faca estéril;
- Pinça estéril;
- Palitos de madeira ou misturadores de plástico;
- Papel toalha; e
- Cuba para descarte de materiais com solução desinfetante.
Equipamentos e instrumentos
- Cabine de Segurança Biológica classe II A2 (preferencial) ou bancada com bico de Bunsen;
- Fluxo laminar com luz UV (opcional);
- Estufa;
- Banho-maria (opcional);
- Esterilizador de alças bacteriológicas (opcional);
- Cronômetro;
- Fonte luminosa para sorologia; e
- Autoclave.
Insumos
- Ágar TSA;
- Ágar nutriente;
- Meio semi-sólido como swarm ágar ou similar (opcional);
- Soro antissomático "O" polivalente de salmonela;
- Soro antiflagelar "H" polivalente de salmonela;
- Soro antissomático "B" (O:4,5) de salmonela;
- Soro antissomático "D" (O:9) de salmonela;
- Soro antiflagelar "H:2" de salmonela;
- Soro antiflagelar "H:i" de salmonela;
- Soro antiflagelar "H:m" de salmonela;
- Soro antiflagelar "H:g" de salmonela;
- Soro antiflagelar "H:q,s,t,p,u” de salmonela ou conjunto com os soros individuais equivalentes (H:q, H:s, H:t, H:p e H:u);
- Cepa de referência de S. Enteritidis;
- Cepa de referência de S. Typhimurium;
- Cepa de referência de S. Pullorum; e
- Cepa de referência de S. Gallinarum.
Insumos opcionais (caracterização ampliada)
- Soro antissomático "C1" (O:6,7) de salmonela;
- Soro antissomático “C2” (O:6,8) de salmonela;
- Soro antiflagelar "H:r" de salmonela;
- Soro antiflagelar “H:5” de salmonela;
- Soro antiflagelar “H:e,n,x” de salmonela;
- Soro antiflagelar “H:z10” de salmonela;
- Soro antiflagelar “H:z15” de salmonela;
- Cepa de referência de S. Heidelberg;
- Cepa de referência de S. Infantis;
- Cepa de referência de S. Hadar; e
- Cepa de referência de S. Virchow.
Soluções
- Solução de Cloreto de Sódio 0,85%; e
- Solução de Cloreto de Sódio 2%.
Realização do ensaio
Considerações gerais
- Retirar da geladeira os antissoros a serem utilizados com antecedência de 15 minutos ao início dos testes, até que atinjam a temperatura ambiente (18 a 25°C);
- Utilizar um controle POSITIVO (cepa de referência) e um NEGATIVO em todas as etapas da caracterização;
- As etapas de inoculação das colônias devem ser feitas obrigatoriamente em cabine de segurança biológica classe II A2 ou bancada com bico de Bunsen;
- Escolher um dos métodos para repique das culturas (inoculação em ágar sólido inclinado ou inoculação em placa para fazer a caracterização ou de acordo com as instruções do fabricante;
- A partir da aglutinação encontrada com os antissoros testados, fazer a interpretação do resultado de acordo com os QUADROS 6 a 9, de acordo com a opção de caracterização antigênica escolhida. O laboratório pode optar por realizar a caracterização antigênica básica (S. Typhimurium, S. Enteritidis, S. Gallinarum e S. Pullorum) ou a ampliada (S. Typhimurium, S. Enteritidis, S. Gallinarum, S. Pullorum, S. Virchow, S. Hadar e S. Infantis);
- Escolher um dos métodos para inversão de fase (técnica da ponte de papel ou em meio semi-sólido);
- A caracterização antigênica pode ser realizada em paralelo com a série bioquímica complementar para a finalização do método de Isolamento de culturas imóveis; e
- O laboratório pode optar por realizar a técnica de microarranjo de DNA ou qPCR para substituir as etapas da caracterização antigênica da colônia.
Técnica da caracterização a partir da inoculação em ágar sólido inclinado
- Inocular a colônia a ser testada em ágar nutriente e incubá-la à temperatura de 37 ± 1°C por 18-24 horas;
- Adicionar 0,5 a 1 mL de solução salina na concentração de 0,85% no tubo de ágar nutriente contendo a bactéria a ser testada;
- Homogeneizar a massa bacteriana na solução salina até a obtenção de um caldo turvo;
- Depositar, separadamente sobre a superfície da placa ou da lâmina de sorologia, uma gota (20 µL ou o recomendado pelo fabricante) do antissoro a ser testado;
- Acrescentar uma gota de suspensão bacteriana sobre cada uma delas;
- Com o auxílio de um palito ou um misturador de plástico, fazer pequenos movimentos circulares para misturar o antissoro e a solução bacteriana, tomando cuidado para evitar respingos e aerossóis;
- Descartar os palitos ou misturadores utilizados;
- Agitar suavemente a placa pelo tempo indicado na bula do fabricante, fazendo movimentos circulares e atentando para a ocorrência da formação de grumos; e
- Realizar a leitura contra a fonte luminosa após o tempo da reação indicado pelo fabricante. O resultado é POSITIVO para o antissoro testado quando houver qualquer grau de formação de grumos.
Técnica da caracterização a partir da inoculação em placa
- Inocular a colônia a ser testada no centro da placa de Petri, contendo o meio semi-sólido encostando levemente a alça na superfície do ágar, tomando o cuidado para não estriar nem perfurar o meio. Inocular apenas uma colônia por placa;
- Incubar à temperatura de 37 ± 1°C por 18-24 horas, mantendo a superfície voltada para cima em superfície plana;
- Inocular cada colônia também em uma placa de Petri com ágar nutriente ou ágar TSA através de estriamento e incubá-la à temperatura de 37 ± 1°C por 18-24 horas;
- Depositar, separadamente sobre a superfície da placa quadriculada ou da lâmina de sorologia, uma gota de cada antissoro a ser testado;
- Com o auxílio de um palito, alça ou um misturador de plástico, recolher massa bacteriana de três pontos do ágar e depositá-la ao lado de cada gota;
- Fazer pequenos movimentos circulares para misturar o antissoro e a massa bacteriana, tomando cuidado para evitar respingos e aerossóis;
- Descartar os palitos ou misturadores;
- Agitar suavemente a placa pelo tempo indicado na bula do fabricante, fazendo movimentos circulares e atentando para a ocorrência da formação de grumos; e
- Realizar a leitura contra a fonte luminosa após o tempo da reação indicado pelo fabricante. O resultado é POSITIVO para o antissoro testado quando houver qualquer grau de formação de grumos.
Teste com salina 2%
- Realizar a caracterização antigênica com a solução salina 2%, pelo tempo de dois minutos de reação;
- As cepas que apresentarem reação negativa com a salina 2% devem ser testadas para o soro “O” para salmonela (caracterização somática);
- Caso a cepa testada apresente reação positiva com a salina 2%, a caracterização antigênica estará inviabilizada, por tratar-se de cepa auto aglutinante. Essa cepa deverá passar por novo processo de purificação, sendo inicialmente enriquecida em caldo Rappaport a 41,5° ± 1°C por 18-24 horas, em seguida passando para a etapa de purificação em ágar Rambach ou XLD e bioquimismo do Isolamento de Salmonela), até chegar novamente na caracterização;
- Na permanência de aglutinação positiva com a salina 2% para a cepa autoaglutinante, o resultado deve ser pré-definido como “Cepa autoaglutinante” e o diagnóstico definitivo do sorovar somente pode ser obtido através da tipificação molecular; e
- Caso não seja possível realizar a tipificação molecular, o resultado deve ser emitido como “Cepa autoaglutinante” no relatório de ensaio.
Caracterização somática
- Realizar a caracterização antigênica com o soro “O” para salmonela;
- As cepas que apresentarem reação negativa com o antissoro “O” são negativas para salmonela;
- Caso a cepa apresente reação positiva com o antissoro “O”, realizar o teste com o antissoro “H” para salmonela;
- As cepas que apresentarem reação positiva com o antissoro “O” e “H” devem ser testadas antigenicamente com os antissoros monovalentes “B” (O:4) e “D” (O:9) de salmonela para caracterização do grupo antigênico. Opcionalmente o laboratório poderá realizar o teste com os antissoros monovalentes “C1” (O:6,7) e “C2” (O:6,8) além dos anteriores (caracterização ampliada); e
- As cepas que apresentarem reação negativa com o antissoro “H” são consideras cepas imóveis e devem ser testadas antigenicamente com o antissoro monovalente “D” (O:9).
Caracterização de cepas imóveis
- Para as cepas imóveis que apresentarem aglutinação positiva para o antissoro “D” (O:9), a caracterização do sorovar deve ser complementada por diferenciação bioquímica, realizada no bioquimismo complementar, sob suspeita de S. Pullorum e S. Gallinarum;
- Na impossibilidade de diferenciação entre os dois sorovares, o resultado deve ser emitido através da fórmula antigênica “S. imóvel (1,9,12: - : - )” e o diagnóstico definitivo somente pode ser realizado através da tipificação por microarranjo de DNA ou qPCR; e
- Caso não seja possível realizar a tipificação por microarranjo de DNA, o resultado deve ser emitido através da fórmula antigênica “S. imóvel (1,9,12: - : - )”.
¶ Caracterização do grupo antigênico
- As cepas positivas para os antissoros “O” e “H” que apresentarem resultados “POSITIVOS” para um dos antissoros monovalentes testados (“B”, “D”, “C1” ou “C2”) deverão passar pela caracterização flagelar correspondente ao sorovar suspeito, seguindo-se o critério a seguir:
- Reação positiva para antissoro “B”: suspeitas de S. Typhimurium e S. Heidelberg;
- Reação positiva para antissoro “D”: suspeitas de S. Enteritidis;
- Reação positiva para antissoro “C1”: suspeitas de S. Infantis e S. Virchow; e
- Reação positiva para antissoro “C2”: suspeitas de S. Hadar.
2. Caso a caracterização flagelar seja realizada a partir da inoculação em placa, retirar a massa bacteriana a partir do meio semi-sólido; e
Nota: Deve-se escolher pontos na borda da placa para a caracterização, tomando cuidado para não retirar parte do ágar.
3. As cepas que apresentarem resultados NEGATIVOS para os antissoros “B” e “D” (obrigatórios – caracterização básica), “C1” e “C2” (optativos – caracterização ampliada) terão diagnóstico pré-definido por Salmonella spp.
¶ Caracterização do sorovar Enteritidis
- Realizar a caracterização flagelar com os antissoros flagelares H:g, H:m e H:q,s,t,p,u e fazer a interpretação do resultado (QUADRO 6);
- A cultura testada é considerada S. Enteritidis caso a aglutinação com os antissoros H:g e H:m seja positiva e com o antissoro H:q,s,t,p,u seja negativa; e
- Cepas cuja caracterização flagelar seja discordante do item 2 terão diagnóstico pré-definido por Salmonella spp.
Caracterização do sorovar Typhimurium
- Realizar a caracterização flagelar com os antissoros flagelares H:i, H:2 e H:r e fazer a interpretação do resultado (QUADRO 6);
- A inversão de fase deve ser realizada nos casos em que apenas um dos antissoros testados (H:i, H:2 ou H:r) apresentar reação positiva. Seguir a técnica da ponte de papel ou a inversão de fase em meio semi-sólido;
- A cultura testada é considerada S. Typhimurium se apresentar reação negativa para o antissoro H:r e um dos resultados a seguir:
- Reação positiva para os antissoros H:i e H:2 diretamente;
- Reação positiva para o antissoro H:i diretamente e positiva com antissoro H:2 após a inversão de fase; e
- Reação positiva para o antissoro H:2 diretamente e positiva com antissoro H:i após a inversão de fase.
4. Cepas cuja caracterização flagelar seja discordante do item 3 terão diagnóstico pré-definido por Salmonella spp.
QUADRO 6. Identificação sorológica dos sorovares de Salmonella (obrigatórios)
| Sorovares de caracterização obrigatória | |||||||||||
| Sal. | Soros somáticos | Soros flagelares (H) | Sorovar | ||||||||
| O | H | B | D | g | m | q,s,t,p,u | i | 1,2 | r | ||
| + | NA | NA | NA | NA | NA | NA | NA | NA | NA | NA | Cepa autoaglutinante a |
| - | + | + | - | - | NA | NA | NA | NA | NA | NA | S. spp.b |
| - | + | - | - | + | NA | NA | NA | NA | NA | NA | S. Gallinarum c |
| - | + | - | - | + | NA | NA | NA | NA | NA | NA | S. Pullorum c |
| - | + | + | - | + | + | + | - | NA | NA | NA | S. Enteritidis |
| - | + | + | - | + | - / + | - / + | + | NA | NA | NA | S. spp.b |
| - | + | + | - | + | - | - | - / + | NA | NA | NA | S. spp.b |
| - | + | + | + | - | NA | NA | NA | + | + | - | S. Typhimurium |
| - | + | + | + | - | NA | NA | NA | + | - | - | S. (1,4,[5],12: i : - ) d |
| - | + | + | + | - | NA | NA | NA | - | + | - | S. (1,4,[5],12: - : 1,2 ) d |
| - | + | + | + | - | NA | NA | NA | - | - | - / + | S. spp.b |
Sal. – Salina 2%; NA – Não aplicável;
a..: O diagnóstico somente pode ser definitivo por meio de tipificação molecular. Na impossibilidade desta análise, providenciar uma nova purificação da cultura e repetir a caracterização ou, em último caso, liberar o resultado como “Cepa autoaglutinante” e, se possível, realizar análise de tipificação por meio de provedor externo credenciado ao MAPA para isolamento e caracterização de salmonelose aviária.
b: O laboratório pode optar pela realização da caracterização final do sorovar por meio da tipificação por microarranjo de DNA ou caracterização completa realizada em laboratório de referência para Salmonela.
c: Confirmar diagnóstico com o resultado do teste de bioquimismo complementar.
d: Seguir para a etapa de inversão de fase para conclusão da caracterização antigênica.
Fonte: adaptado de GRIMONT & WEILL, 2007.
Caracterização do sorovar Heidelberg – Opcional (caracterização ampliada)
- Realizar a caracterização flagelar com os antissoros flagelares H:i, H:2 e H:r e fazer a interpretação do resultado (QUADRO 7);
- A inversão de fase deve ser realizada nos casos em que apenas um dos antissoros testados (H:i, H:2 ou H:r) apresentar reação positiva. Seguir a técnica da ponte de papel ou a inversão de fase em meio semi-sólido;
- A cultura testada é considerada S. Heidelberg se apresentar reação negativa para o antissoro H:i e um dos resultados a seguir:
- Reação positiva para os antissoros H:2 e H:r diretamente;
- Reação positiva para o antissoro H:2 diretamente e positiva com antissoro H:r após a inversão de fase; e
- Reação positiva para o antissoro H:r diretamente e positiva com antissoro H:2 após a inversão de fase.
4. Cepas cuja caracterização flagelar seja discordante do item c) terão diagnóstico pré-definido por Salmonella spp.
Caracterização dos sorovares Infantis e Virchow - Opcional (caracterização ampliada)
- Realizar a técnica de aglutinação em placa com os antissoros flagelares H:5, H:2 e H:r e fazer a interpretação do resultado (QUADRO 7);
- A inversão de fase deve ser realizada nos casos em que apenas um dos antissoros testados (H:5, H:2 ou H:r) apresentar reação positiva. Seguir a técnica de ponte de papel ou inversão de fase em meio semi-sólido;
- A cultura testada é considerada S. Infantis se apresentar reação negativa para o antissoro H:2 e um dos resultados a seguir:
- Reação positiva para os antissoros H: r e H:5 diretamente;
- Reação positiva para o antissoro H:r diretamente e positiva com antissoro H:5 após a inversão de fase; e
- Reação positiva para o antissoro H:5 diretamente e positiva com antissoro H:r após a inversão de fase.
4. A cultura testada é considerada S. Virchow se apresentar reação negativa para o antissoro H:5 e um dos resultados a seguir:
- Reação positiva para os antissoros H:2 e H:r diretamente;
- Reação positiva para o antissoro H:2 diretamente e positiva com antissoro H:r após a inversão de fase; e
- Reação positiva para o antissoro H:r diretamente e positiva com antissoro H:2 após a inversão de fase.
5. Cepas cuja caracterização flagelar seja discordante dos itens 3 e 4 terão diagnóstico pré-definido por Salmonella spp.
QUADRO 7. Identificação sorológica dos sorovares de Salmonella (opcionais) – caracterização ampliada
| Sorovares de caracterização opcional | ||||||||||||||
|---|---|---|---|---|---|---|---|---|---|---|---|---|---|---|
| Sal | Soros somáticos | Soros flagelares | Sorovar | |||||||||||
| O | H | B | C1 | C2 | D | z10 | z15 | e,n,x | i | 1,2 | r | 1,5 | ||
| - | + | + | - | - | - | - | NA | NA | NA | NA | NA | NA | NA | S. spp.a |
| - | + | + | - | + | - | - | + | - | + | NA | NA | NA | NA | S. Hadar |
| - | + | + | - | + | - | - | + | - | - | NA | NA | NA | NA | S. (6,8: z10: - ) b |
| - | + | + | - | + | - | - | - | - | + | NA | NA | NA | NA | S. (6,8: - : e,n,x ) b |
| - | + | + | - | + | - | - | + / - | + | + / - | NA | NA | NA | NA | S. spp.a |
| - | + | + | - | + | - | - | - | + / - | - | NA | NA | NA | NA | S. spp.a |
| - | + | + | + | - | - | - | NA | NA | NA | - | + | + | NA | S. Heidelberg |
| - | + | + | + | - | - | - | NA | NA | NA | - | + | - | NA | S. (1,4,[5],12: - : 1,2 ) b |
| - | + | + | + | - | - | - | NA | NA | NA | - | - | + | NA | S. (1,4,[5],12: r : - ) b |
| - | + | + | - | - | + | - | NA | NA | NA | NA | - | + | + | S. Infantis |
| - | + | + | - | - | + | - | NA | NA | NA | NA | + | + | - | S. Virchow |
| - | + | + | - | - | + | - | NA | NA | NA | NA | - | - | + | S. (6,7,14: - : 1,5) b |
| - | + | + | - | - | + | - | NA | NA | NA | NA | - | + | - | S. (6,7,14: - : 1,2) b |
| - | + | + | - | - | + | - | NA | NA | NA | NA | + | - | - | S. (6,7,14: r : - ) b |
| - | + | + | - | - | + | - | NA | NA | NA | NA | - | - | - | S. spp.a |
Sal – Salina 2%; NA – Não aplicável;
a : O laboratório pode optar pela realização da caracterização final do sorovar através da tipificação molecular, ou caracterização completa realizada em laboratório de referência para salmonela.
b : Seguir para a etapa de inversão de fase para conclusão da caracterização antigênica.
Fonte: adaptado de GRIMONT & WEILL, 2007
Cepas de Salmonella spp.
O laboratório credenciado pode optar por realizar a identificação final do sorovar com diagnóstico pré-definido como Salmonella spp. Nesse caso, somente poderão ser utilizadas as técnicas de tipificação molecular ou caracterização antigênica completa (realizada por provedor externo), a fim de ser obtido o sorovar definitivo. A técnica deve ser identificada no Resultado.
Inversão de fase pela técnica da ponte de papel
- Realizar a inversão de fase em culturas suspeitas de S. Typhimurium, S. Heidelberg, S. Hadar, S. Infantis e S. Virchow em que houver somente a expressão de um dos flagelos para o sorovar suspeito;
- Separar uma placa com ágar TSA para cada três colônias testadas. Traçar duas linhas paralelas de um lado a outro da placa, posicionadas no centro da placa, com 1 cm de distância entre si. Identificar uma das regiões como 1 (Pré-Inversão) e 2 (Pós-Inversão);
- Cortar o ágar nas linhas traçadas, com o auxílio de lâmina ou faca estéril, e remover o ágar do centro, de forma que sobrem duas regiões separadas do meio ao final (FIGURA 3);
- Secar as placas em fluxo laminar ou cabine de segurança biológica, abrindo-as parcialmente com o ágar voltado para cima;
- Inserir até três tiras de papel filtro estéril sobre o espaço cortado, equidistantes, de forma que cada extremidade ligue um lado ao outro do ágar. Deve-se manipular as tiras sem que elas dobrem ou encostem na superfície inferior da placa, pressionando bem suas extremidades para aderirem ao ágar (FIGURA 3);
- Depositar sobre a região de cada fita que não faz contato com o ágar (meio), uma gota da solução do soro antiflagelar (aproximadamente 30 µL) a ser utilizado na inversão, de forma a cobrir totalmente a largura das fitas. Deve ser utilizado o antissoro cuja expressão foi positiva durante a caracterização antigênica. As tiras devem estar úmidas com o antissoro durante a inoculação;
- Caso seja utilizado soro antiflagelar próprio para inversão de fase, utilizar a quantidade indicada pelo fabricante;
- Inocular a colônia a ser testada sobre a extremidade da tira que está em contato com a região de pré-inversão (1), conforme indicado na Figura 3. Podem ser testadas até três colônias diferentes numa mesma placa, uma em cada tira;
- Incubar as placas a 37 ± 1°C por 16-18 horas, sem exceder o tempo total de incubação;
- Após a incubação, a colônia com a fase invertida deve migrar para a região 2 (pós inversão). Fazer o repique de uma colônia de ambas as regiões em ágar nutriente, incubando a 37 ± 1°C por 18-24 horas, e repetir a caracterização flagelar do sorovar suspeito. Realizar o repique mesmo que não seja perceptível o crescimento da colônia a olho nu; e
- Repetir a caracterização flagelar das cepas invertidas e fazer a interpretação a partir dos perfis dispostos no QUADRO 8 e no QUADRO 9.
FIGURA 3. Esquematização da montagem da ponte de papel para inversão de fase

Inversão de fase em meio semi-sólido
- Realizar a inversão de fase em culturas suspeitas de S. Typhimurium, S. Heidelberg, S. Hadar, S. Infantis e S. Virchow em que houver somente a expressão de um dos flagelos para o sorovar suspeito;
- Fundir o meio semi-sólido a 95 °C em banho-maria. Resfriar em seguida, mantendo a 45 °C;
- Adicionar 100 μL do soro antiflagelar a ser utilizado na inversão em uma placa de Petri estéril. Deve ser utilizado o antissoro cuja expressão foi positiva durante a caracterização antigênica;
- Caso seja utilizado soro antiflagelar próprio para inversão de fase, utilizar a quantidade indicada pelo fabricante;
- Distribuir entre 10 e 30 mL do meio na mesma placa. O volume a ser utilizado depende do tamanho da placa utilizada. Homogeneizar o meio com movimento suave e esperar solidificar;
- Inocular a colônia a ser testada no centro da placa, encostando levemente a alça na superfície do ágar, tomando o cuidado para não estriar nem perfurar o meio. Inocular apenas uma colônia por placa;
- Incubar à temperatura de 37 ± 1°C por 18-24 horas, mantendo a superfície voltada para cima em superfície plana;
- Repetir a caracterização flagelar do sorovar suspeito utilizando a massa da cultura localizada nas bordas do crescimento bacteriano e fazer a interpretação a partir dos perfis dispostos no QUADRO 8 e no QUADRO 9; e
- Caso o crescimento da cultura seja pontual, não se espalhando por toda a superfície, é provável que a cultura em questão seja monofásica. Repetir a caracterização flagelar do sorovar suspeito mesmo neste caso.
QUADRO 8. Identificação sorológica dos sorovares de Salmonella após inversão de fase dos sorovares Typhimurium (obrigatório) e Heidelberg (opcional)
| Inversão de fase – S. Typhimurium (obrigatório) e S. Heidelberg (opcional) | |||||
|---|---|---|---|---|---|
| Fórmula antigênica | Soro para inversão | Sorologia após inversão de fase | Diagnóstico final | ||
| i | 1,2 | r | |||
| S. (1,4,[5],12: i : - ) | i | - | + | - | S. Typhimurium |
| S. (1,4,[5],12: i : - ) | i | + | - | - | S. (1,4,[5],12: i : * ) a |
| S. (1,4,[5],12: - : 1,2 ) | 1,2 | + | - | - | S. Typhimurium |
| S. (1,4,[5],12: - : 1,2 ) | 1,2 | - | - | + | S. Heidelberg |
| S. (1,4,[5],12: - : 1,2 ) | 1,2 | - | + | - | S. (1,4,[5],12: * : 1,2 ) a |
| S. (1,4,[5],12: r : - ) | r | - | + | - | S. Heidelberg |
| S. (1,4,[5],12: r : - ) | r | - | - | + | S. (1,4,[5],12: r : * ) a |
a : O diagnóstico somente pode ser definitivo por meio de tipificação por microarranjo de DNA. Na impossibilidade desta análise pelo laboratório, emitir o resultado com a fórmula antigênica sugerida no quadro, deixando na nota do laudo a frase a seguir: “*: Não foi possível identificar a respectiva fase durante a caracterização”.
b : Amostras que apresentarem ausência de crescimento após a inversão de fase, inviabilizando a conclusão da caracterização sorológica, somente podem ser caracterizadas por tipificação molecular. Na impossibilidade desta análise pelo laboratório, emitir o resultado com a fórmula antigênica apresentada no quadro.
Fonte: adaptado de GRIMONT & WEILL, 2007.
QUADRO 9. Identificação sorológica dos sorovares Hadar, Virchow e Infantis após inversão de fase (opcionais)
| Inversão de fase – S. Hadar, S. Infantis e S. Virchow (opcionais) | ||||||||
|---|---|---|---|---|---|---|---|---|
| Fórmula antigênica | Soro para inversão | Sorologia após inversão de fase b | Diagnóstico final | |||||
| z10 | z15 | e,n,x | 1,2 | r | 1,5 | |||
| S. (6,8: z10: - ) | z10 | - | - | + | NA | NA | NA | S. Hadar |
| S. (6,8: z10: - ) | z10 | + | - | - | NA | NA | NA | S. (6,8: z10: * ) a |
| S. (6,8: - : e,n,x ) | e,n,x | + | - | - | NA | NA | NA | S. Hadar |
| S. (6,8: - : e,n,x ) | e,n,x | - | - | + | NA | NA | NA | S. (6,8: * : e,n,x ) a |
| S. (6,7,14: - : 1,5) | 1,5 | NA | NA | NA | - | - | + | S. (6,7,14: * : 1,5) a |
| S. (6,7,14: r : - ) | r | NA | NA | NA | - | - | + | S. Infantis |
| S. (6,7,14: r : - ) | r | NA | NA | NA | + | - | - | S. Virchow |
| S. (6,7,14: r : - ) | r | NA | NA | NA | - | + | - | S. (6,7,14: r : * ) a |
| S. (6,7,14: - : 1,2) | 1,2 | NA | NA | NA | - | + | - | S. Virchow |
| S. (6,7,14: - : 1,2) | 1,2 | NA | NA | NA | + | - | - | S. (6,7,14: * : 1,2) a |
A – Não aplicável;
a : O diagnóstico somente pode ser definitivo por meio de tipificação molecular. Na impossibilidade desta análise pelo laboratório, emitir o resultado com a fórmula antigênica sugerida no quadro, deixando na nota do laudo a frase a seguir: “*: Não foi possível identificar a respectiva fase durante a caracterização”.
b : Amostras que apresentarem ausência de crescimento após a inversão de fase, inviabilizando a conclusão da caracterização sorológica, somente podem ser caracterizadas por tipificação por microarranjo de DNA. Na impossibilidade desta análise pelo laboratório, emitir o resultado com a fórmula antigênica apresentada no quadro.
Critérios de Aceitação
- O crescimento bacteriano das culturas testadas deve ser satisfatório nos ágares inoculados, após o período de incubação. Deve-se repetir o repique de quaisquer culturas com ausência de crescimento;
- As etapas de caracterização somática e flagelar não podem ser concluídas se a cepa apresentar aglutinação positiva com salina 2% (culturas autoaglutinantes);
- Os controles POSITIVOS e NEGATIVOS utilizados devem apresentar resultados compatíveis com sua fórmula antigênica, não podendo apresentar reações positivas com antissoros NEGATIVOs e vice-versa;
- A inversão de fase em ponte de papel somente é válida se houver crescimento a olho nu na fase 1 (pré-inversão), pelo tempo máximo de incubação; e
- A inversão de fase em meio semi-sólido somente é válida se houver o crescimento da cultura no ágar após o tempo de incubação.
Interpretação dos resultados
- Repetir a caracterização flagelar das cepas invertidas e fazer a interpretação a partir dos perfis dispostos no QUADROS 8 e no QUADRO 9;
- Caso a cepa após inversão de fase apresente os mesmos resultados que o encontrado na primeira caracterização, a inversão de fase deve ser repetida;
- Na ausência de crescimento da cultura incubada em ágar nutriente (no caso da técnica da ponte de papel), ou caso o resultado encontrado na segunda caracterização seja inconclusivo ou discordante com os Quadros 8 e 9, o resultado preliminar deve ser expresso com a fórmula antigênica, de acordo com o disposto nesses quadros (cepa monofásica); e
- O diagnóstico definitivo dessas cepas somente pode ser realizado através da tipificação molecular.
Emissão dos resultados
Os resultados deverão ser emitidos e expressos como POSITIVO ou “NEGATIVO”, contendo os itens a seguir:
- as matrizes das quais se obteve o resultado POSITIVO, expressando a quantidade de matrizes positivas dentre o total de analisadas;
- o sorovar identificado na etapa de caracterização, identificando as matrizes das quais foi isolado; e
Nota: No caso de isolamento de Salmonela monofásica descrever a fórmula antigênica.
- as técnicas utilizadas.
Descarte das amostras e resíduos
- Antes da realização do descarte de amostras e produtos de ensaio deverão ser observados os prazos mínimos estabelecidos no item “Retenção de Itens de Ensaio”;
- Os materiais descartados devem ser separados adequadamente entre resíduos químicos e biológicos;
- Todo o resíduo biológico do ensaio deve ser imerso em cuba com solução de ácido cítrico 0,2%, hipoclorito de sódio 0,5% ou solução para descontaminação similar, por no mínimo 1 hora;
- Após este período, todo resíduo biológico do ensaio deve ser submetido ao processo de autoclavação apropriado. A efetividade da esterilização deve estar comprovada em procedimentos próprios do laboratório e devem ser utilizados controles físicos, químicos e biológicos para o monitoramento do processo; e
- O laboratório deve assegurar a biossegurança dos resíduos gerados, e seguir as legislações ambientais vigentes durante todo o processo do descarte.
Retenção de itens de ensaio
Culturas de salmonela
Após um período mínimo de 03 anos da realização das análises, as amostras poderão ser descartadas, registrando-se em formulários próprios e conferidas antes do descarte.
¶ F. Identificação do agente - Tipificação molecular por microarranjo de DNA
Materiais
- Luvas de procedimento nitrílica ou de látex isentas de pó;
- Alças bacteriológicas descartáveis ou flambáveis;
- Microtubos ou microplacas de volumes variados;
- Ponteiras com filtro, estéreis, livres de DNAses e RNAses;
- Estantes para microtubos;
- Caneta para escrita em plástico/vidro;
- Algodão, gaze ou papel toalha;
- Palitos ou hastes descartáveis; e
- Cuba para descarte com solução desinfetante (opcional).
Equipamentos e instrumentos
- Cabine de segurança biológica classe II ou estação de trabalho para PCR (Workstation PCR) com luz UV;
- Esterilizador de alças bacteriológicas (opcional);
- Micropipetas mono e multicanais de volumes reguláveis;
- Termobloco;
- Termomixer;
- Mini centrífuga;
- Vórtex;
- Leitor de plataforma de microarranjo de DNA;
- Microcomputador; e
- Autoclave.
Insumos
- Ágar TSA ou nutriente ou Rambach ou XLD; e
- Kit para tipificação molecular por microarranjo de DNA.
Soluções
- Solução de álcool 70º INPM;
- Solução descontaminante de moléculas residuais de RNAs / DNAs / amplicons /resíduos de proteínas de superfícies, entre as quais DNAses/RNAses; e
- Solução de hipoclorito de sódio 2% (opcional).
Realização do ensaio
Considerações gerais
- Esta técnica substitui a caracterização antigênica de salmonela; e
- As etapas de bioquimismo do método de Isolamento de Salmonela são facultativas, se for optado pelo uso dessa técnica.
Preparo da cultura
A cultura para a realização do ensaio deve ser obtida a partir da etapa de purificação do isolamento em ágar seletivo (ágar XLD, Rambach) ou em ágar não seletivo (TSA ou nutriente); e
No caso de material fecal, materiais ambientais ou suabes, o ensaio poderá ser realizado a partir de culturas retiradas diretamente do MSRV, desde que seja indicado pelo fabricante do kit.
Realização da técnica
- Realizar o ensaio em salas separadas, não comunicáveis, para cada etapa do procedimento e com equipamentos e instrumentos exclusivos para cada sala;
- Realizar todas as etapas que envolvam a manipulação de cultura viva em cabine de segurança biológica ou no raio da chama do bico de Bunsen;
- Realizar a preparação do mix em Workstation ou cabine de segurança biológica;
- Antes e após a adição das amostras e do mix de reação, descontaminar a Workstation, cabine de segurança biológica, bancadas e os materiais a serem utilizados com solução descontaminante de moléculas residuais de RNAs / DNAs / amplicons /resíduos de proteínas de superfícies, entre as quais DNAses/RNAses e/ou álcool 70º INPM; e
- As micropipetas utilizadas para o preparo do mix de reação e adição das amostras devem ser exclusivas para tais finalidades.
Critérios de aceitação da prova
O ensaio é considerado válido se a leitura do controle interno do kit apresentar resultado satisfatório.
Interpretação dos resultados
- Fazer a leitura através de software, seguindo instruções do fabricante do kit;
- Ao finalizar, salvar os dados e interpretar os resultados; e
- Qualquer amostra com resultado inconclusivo ou com suspeitas de contaminação deverá ser retestada.
Emissão dos resultados
Os resultados deverão ser expressos como “POSITIVO” ou “NEGATIVO”, contendo os itens a seguir:
- As matrizes das quais se obteve o resultado POSITIVO, expressando a quantidade de matrizes positivas dentre o total de analisadas;
- O sorovar identificado na etapa de caracterização, identificando as matrizes das quais foi isolado; e
- As técnicas utilizadas.
Descarte das amostras e resíduos
- Antes da realização do descarte de amostras e produtos de ensaio deverão ser observados os prazos mínimos estabelecidos no item “Retenção de itens de ensaio”;
- Os materiais descartados devem ser separados adequadamente entre resíduos químicos e biológicos;
- Todo o resíduo biológico do ensaio deve ser submetido ao processo de autoclavação apropriado. A efetividade da esterilização deve estar comprovada em procedimentos próprios do laboratório e devem ser utilizados controles físicos, químicos e biológicos para o monitoramento do processo; e
- O laboratório deve assegurar a biossegurança dos resíduos gerados, e seguir as legislações ambientais vigentes durante todo o processo do descarte.
Retenção de itens de ensaio
Culturas de salmonela
Após um período mínimo de 03 anos da realização das análises, as amostras poderão ser descartadas, registrando-se em formulários próprios e conferidas antes do descarte.
Produtos de extração
Imediatamente após a emissão do resultado poderão ser descartados, registrando-se em formulários próprios e conferidas antes do descarte
¶ G. Triagem molecular e Identificação molecular do agente - PCR em tempo real para Salmonella spp.
Nota: O laboratório pode optar por realizar a técnica de PCR em tempo real com um kit comercial ou protocolo “in house”. Ambos necessitam de comprovação de desempenho.
Materiais
- Luvas de procedimento nitrílicas ou de látex isentas de pó;
- Microtubos de volumes variados ou microplacas;
- Microplacas ou microtubos para leitura óptica de qPCR;
- Tampas adesivas para microplacas para leitura óptica de qPCR;
- Ponteiras com filtro, estéreis, livres de DNAses e RNAses;
- Estantes para microtubos; e
- Gaze ou papel toalha.
Equipamentos e instrumentos
- Cabine de segurança biológica classe II ou estação de trabalho para PCR (Workstation PCR) com luz UV germicida;
- Geladeira;
- Freezer;
- Micropipetas mono e multicanais de volumes reguláveis;
- Termociclador para PCR em tempo real;
- Centrífuga para microtubos;
- Agitador de microtubos;
- Microcomputador;
- Equipamento para extração automatizada de ácidos nucleicos (opcional); e
- Autoclave.
Insumos
- Água livre de nucleases;
- Oligonucleotídeos para qPCR (QUADRO 10);
- Controle DETECTADO para Salmonella spp.;
- Kit de qPCR; e
- Kit para extração de DNA (manual ou automatizado).
QUADRO 10. Sugestão de oligonucleotídeos para detecção molecular por qPCR de Salmonella spp.
| Oligonucleotídeo | Sequência | Referência |
| ttr-6 (forward) | CTCACCAGGAGATTACAACATGG | Malorny, 2004 |
| ttr-4 (reverse) | AGCTCAGACCAAAAGTGACCATC | Malorny, 2004 |
| ttr-5 (probe) | FAM-CACCGACGGCGAGACCGACTTT-Dark Quencher | Malorny, 2004 |
Soluções
- Solução de álcool 70º INPM;
- Solução descontaminante de moléculas residuais de RNAs / DNAs / amplicons /resíduos de proteínas de superfícies, entre as quais DNAses/RNAses; e
- Solução de hipoclorito de sódio 0,5%.
Realização do ensaio
Extração de ácidos nucleicos
- Realizar a extração de ácidos nucleicos das amostras incubadas utilizando kit de extração de DNA específico para o tipo de material a ser analisado, de acordo com as recomendações do fabricante;
- O laboratório pode optar pelo uso de outro método de extração que não use kit, desde que apresente verificação de desempenho comprovada pelo próprio laboratório;
- A etapa de incubação (enriquecimento em caldos) poderá ser facultativa desde que o laboratório possua um método de PCR validado com limite de detecção tão eficiente quanto o método de Isolamento ou a extração após essa etapa; e
- Adicionar amostras controle a cada procedimento de extração: controle POSITIVO (Salmonella spp.) e controle NEGATIVO (caldo de enriquecimento ou água).
Reação de amplificação de ácido nucleico
- Realizar o ensaio em duas áreas separadas: uma para o preparo do mix de reação (sala de pré-PCR) isenta de material genético e amplicons, e outra para a transferência de DNA para placa ou microtubos (sala de PCR);
- Antes e após o preparo do mix de reação, descontaminar a cabine e os materiais a serem utilizados com Solução descontaminante de moléculas residuais de RNAs / DNAs / amplicons /resíduos de proteínas de superfícies, entre as quais DNAses/RNAses;
- e nucleases) e/ou álcool 70 INPM; e
- As micropipetas utilizadas para o preparo do mix de reação e adição das amostras devem ser exclusivas para tais finalidades.
Preparo do mix de reação
- Preparar o mix de reação de acordo com protocolos validados e específicos para o agente pesquisado (Salmonella spp.) em quantidade suficiente para o número de amostras a serem testadas;
- Após o preparo do mix, adicionar o DNA nos poços da placa ou em microtubos para leitura óptica;
- A adição de DNA e das amostras controle deve ser realizada em uma área distinta do preparo do mix (sala de PCR); e
- Devem ser incluídos nas análises:
- Controle POSITIVO (Salmonella spp.);
- Controle NÃO DETECTADO da extração;
- Branco (água livre de nucleases) e
- Controle DETECTADO e NÃO DETECTADO do kit utilizado (se houver).
Reação de qPCR
- Selar a placa com adesivo óptico ou fechar a tampa dos microtubos. Verificar se há bolhas no fundo do poço e/ou gotículas na parede dos poços da placa ou tubo. Caso isto ocorra, centrifugar brevemente para reduzir as bolhas e para que o conteúdo se posicione na parte inferior da placa ou tubo;
- Iniciar e entrar com os dados no software do termociclador (identificação das amostras e seleção dos fluoróforos), conforme especificações do fabricante;
- Inserir a placa ou os tubos no termociclador, salvar o arquivo e iniciar a corrida; e
- Ao finalizar, salvar os dados e interpretar os resultados.
Critérios de aceitação do ensaio
- Para a validação do ensaio, o controle POSITIVO do kit e o controle interno devem apresentar uma curva sigmoide (em forma de S) e um Cq satisfatório (conforme especificações do fabricante); e
- O controle NEGATIVO deve ter Cq indeterminado ou maior que o limite do kit. O gráfico do controle NEGATIVO deve apresentar traços de fluorescência na linha de base durante todo o ensaio. Esses traços não devem apresentar curva sigmoide ou um aumento gradual na fluorescência.
Interpretação dos resultados
- Ao analisar os resultados da corrida, o operador deve avaliar os seguintes componentes: controle POSITIVO, controle NEGATIVO, controle da extração, background de fluorescência e gráficos de amplificação de cada amostra individualmente. Após a validação do ensaio, interpretar os resultados conforme especificações do fabricante;
- Qualquer amostra questionável deverá ser retestada;
- Qualquer amostra cujo resultado seja POSITIVO na PCR deverá passar pela técnica de Isolamento de Salmonela ou por PCR específico para os sorovares do PNSA, conforme a seguir:
- Órgãos e tecidos: S. Gallinarum, S. Pullorum, S. Enteritidis e S. Typhimurium; e
- Material fecal e ambiental: S. Enteritidis e S. Typhimurium.
4. A realização do PCR específico para os sorovares do PNSA pode ser realizada de forma a complementar o Isolamento em qualquer uma de suas etapas, desde que a verificação de desempenho realizada pelo laboratório tenha contemplado essa possibilidade.
Emissão dos resultados
Os resultados deverão ser emitidos e expresso como “POSITIVO” ou “NEGATIVO”, contendo os itens a seguir:
- As matrizes das quais se obteve o resultado POSITIVO, expressando a quantidade de matrizes positivas dentre o total de analisadas;
Nota: Caso a PCR utilizada seja específica para as Salmonelas do PNSA e o resultado seja negativo, deve ser expresso como Salmonella spp.
- O sorovar identificado na etapa de caracterização, identificando as matrizes das quais foi isolado; e
- As técnicas utilizadas.
Descarte das amostras e resíduos
- Antes da realização do descarte de amostras e produtos de ensaio deverão ser observados os prazos mínimos estabelecidos no item “Retenção de itens de ensaio”;
- Os materiais descartados devem ser separados adequadamente entre resíduos químicos e biológicos;
- Todo o resíduo biológico do ensaio deve ser submetido ao processo de autoclavação apropriado. A efetividade da esterilização deve estar comprovada em procedimentos próprios do laboratório e devem ser utilizados controles físicos, químicos e biológicos para o monitoramento do processo; e
- O laboratório deve assegurar a biossegurança dos resíduos gerados, e seguir as legislações ambientais vigentes durante todo o processo do descarte.
Retenção de itens de ensaio
Produtos de extração
Imediatamente após a emissão do resultado poderão ser descartados, registrando-se em formulários próprios e conferidas antes do descarte.
¶ H. Triagem molecular - PCR pelo Sistema BAX ® para Salmonella spp.
Materiais
- Luvas de procedimento nitrílicas ou de látex isentas de pó;
- Microtubos de volumes variados ou microplacas;
- Ponteiras com filtro, estéreis, livres de DNAses e RNAses;
- Pinça e tesoura estéreis;
- Estantes para microtubos;
- Gaze ou papel toalha; e
- Cuba para descarte com solução desinfetante (opcional).
Equipamentos e instrumentos
- Cabine de segurança biológica com filtro HEPA classe II ou estação de trabalho para PCR (Workstation PCR) com luz UV germicida;
- Estufa;
- Geladeira;
- Freezer;
- Micropipetas mono e multicanais de volumes reguláveis;
- Provetas estéreis (opcional);
- Termobloco;
- Balança semi-analítica;
- Agitador tipo vórtex;
- Homogeneizador de amostras (opcional);
- Sistema BAX ®;
- Microcomputador; e
- Autoclave.
Insumos
Água peptonada;
Caldo BHI;
Solução de hipoclorito de sódio 2% (opcional); e
Kit para PCR pelo Sistema BAX.
¶ Soluções
Água peptonada;
Caldo BHI;
Solução de álcool 70º INPM;
Solução descontaminante de moléculas residuais de RNAs / DNAs / amplicons /resíduos de proteínas de superfícies, entre as quais DNAses/RNAs (opcional); e
Solução de hipoclorito de sódio 2% (opcional).
Realização do ensaio
Considerações gerais
Este método pode ser utilizado como uma etapa de triagem antes da técnica de Isolamento de Salmonela.
Preparo da amostra
Mecônio, gema e fezes frescas
- Adicionar 2 g em 20 mL de água peptonada 1% e incubar em estufa a 37 °C ± 1°C por 18-24 horas;
- Homogeneizar e inocular 10 µL do líquido em 500 µL de caldo BHI e incubar a 37 °C 2 °C por 3 horas; e
- Processar conforme protocolo do kit.
Suabe de fundo de caixa, papel de fundo de caixa e suabe de cloaca
Adicionar aproximadamente 20-50 mL de água peptonada 1% ou na proporção 1:10 em quantidade suficiente para cobrir o material com o líquido, e incubar em estufa a 37 °C ± 1°C por 18-24 horas;
Homogeneizar e inocular 10 µL do líquido em 500 µL de caldo BHI e incubar a 37 °C 2 °C por 3 horas; e
Processar conforme protocolo do kit.
Realização do PCR
- Seguir os protocolos para análise conforme descrito no manual de fabricante;
- Realizar o ensaio em salas separadas para cada etapa do procedimento, conforme exigências do protocolo específico;
- Antes e após a adição das amostras e do mix de reação, descontaminar a cabine e os materiais a serem utilizados com solução descontaminante de moléculas residuais de RNAs / Donas / amplicons /resíduos de proteínas de superfícies, entre as quais DNAses/RNAses e/ou álcool 70º INPM;
- As micropipetas utilizadas para o preparo do mix de reação e adição das amostras devem ser exclusivas para tais finalidades; e
- Devem ser incluídos nas análises:
- Controle POSITIVO para Salmonella spp.;
- Controle NEGATIVO para a extração; e
- Controles do kit utilizado (se houver).
Critérios de aceitação da prova
O ensaio é considerado válido se a leitura do controle interno do kit apresentar resultado satisfatório.
Interpretação dos resultados
- Fazer a leitura através de software, seguindo instruções do fabricante do kit;
- Ao finalizar, salvar os dados e interpretar os resultados;
- Qualquer amostra com resultado inconclusivo deverá ser retestada;
Qualquer amostra cujo resultado seja POSITIVO deverá passar pela técnica de isolamento de salmonela
Emissão dos resultados
Os resultados deverão ser emitidos e expressos como “POSITIVO” ou “NEGATIVO”, contendo os itens a seguir:
- As matrizes das quais se obteve o resultado POSITIVO, expressando a quantidade de matrizes positivas dentre o total de analisadas;
- O sorovar identificado na etapa de caracterização, identificando as matrizes das quais foi isolado; e
- As técnicas utilizadas.
Descarte das amostras e resíduos
- Antes da realização do descarte de amostras e produtos de ensaio deverão ser observados os prazos mínimos estabelecidos no item “Retenção de Itens de Ensaio;
- Os materiais descartados devem ser separados adequadamente entre resíduos químicos e biológicos;
- Todo o resíduo biológico do ensaio deve ser submetido ao processo de esterilização por autoclavação. A efetividade da esterilização deve estar comprovada em procedimentos próprios do laboratório e devem ser utilizados controles físicos, químicos e biológicos para o monitoramento do processo; e
- O laboratório deve assegurar a biossegurança dos resíduos gerados, e seguir as legislações ambientais vigentes durante todo o processo do descarte.
Retenção de Itens de Ensaio
Amostras
Imediatamente após a emissão do laudo, as amostras poderão ser descartadas, registrando-se em formulários próprios e conferidas antes do descarte.
Produtos de extração
Imediatamente após a emissão do laudo, as amostras poderão ser descartadas, registrando-se em formulários próprios e conferidas antes do descarte.
¶ 4.2 MICOPLASMOSE AVIÁRIA
4.2.1. Amostras
São consideradas amostras para o diagnóstico da Micoplasmose Aviária:
4.2.1.1. Detecção da Resposta Imune
Soro sanguíneo.
4.2.1.2. Identificação do agente
a)Traqueia;
b)Suabe de traqueia; e
c)Ovos bicados, aves mortas e pintos de um dia (órgãos e tecidos).
4.2.2.Recebimento das Amostras
4.2.2.1. Para atendimento aos Programas e Controles Oficiais do MAPA os Laboratórios credenciados somente receberão as amostras previstas na legislação em vigor para as finalidades e ensaios previstos no seu escopo de credenciamento; e
4.2.2.2. Deverão ser obedecidos os critérios estabelecidos no capítulo de verificação de conformidade de amostras.
4.2.3.Técnicas de Diagnóstico
4.2.3.1. Somente poderão ser utilizados insumos de diagnóstico que tenham registro no MAPA, segundo legislação em vigor;
4.2.3.2. Todos os insumos utilizados na análise devem ser controlados e previamente testados e aprovados;
4.2.3.3. O laboratório deverá realizar os ensaios obedecendo as temperaturas preconizadas pelo fabricante dos insumos:
a)Quando essa informação não constar na bula o laboratório deverá consultar o fabricante, mesmo que a indicação seja de realização a temperatura ambiente;
b)Quando não informado pelo fabricante, serão considerados como temperatura ambiente, valores de temperatura entre 18 e 25°C.
4.2.3.4. Antes da utilização dos insumos, realizar a avaliação de todos os parâmetros referentes aos lotes e valores de ponto de corte dos critérios de interpretação dos resultados;
4.2.3.5. O laboratório deve estabelecer um meio de avaliação apropriado para todos os insumos utilizados nos ensaios;
4.2.3.6. Devem ser retidos os registros dos controles dos ensaios realizados, devendo ser registrada data e responsável de todas as etapas realizadas para cada amostra analisada;
4.2.3.7.Os resultados encontrados para cada amostra e controles, dados dos insumos utilizados e outras informações pertinentes devem ser registrados em formulários próprios e/ou sistema informatizado do próprio laboratório;
Nota: A utilização de sistemas informatizados para registros apenas é permitido quando:
I. A inclusão dos dados for realizada durante a execução e leitura do ensaio, sem anotação prévia em formulários de papel. Dados transcritos não são considerados dados brutos.
II. As alterações de informações estejam prontamente disponíveis e rastreáveis, sem a necessidade de intervenção de especialistas em informática ou geração de logs ou equivalentes.
III. O dado anterior, o responsável pela alteração e a data da realização da alteração estiver prontamente disponível.
¶ A.Detecção da Resposta Imune - Ensaio Imunoenzimático (ELISA)
Materiais
- Luvas para procedimentos;
- Pipetas de vidro graduadas ou descartáveis;
- Provetas graduadas;
- Béqueres;
- Erlenmeyers;
- Ponteiras descartáveis;
- Reservatórios para soluções (cubas);
- Papel absorvente;
- Selador ou tampa para placas de ELISA;
- Caneta para identificação de vidraria; e
- Cubas para descarte de materiais resistente à autoclavação.
Equipamentos e instrumentos
- Geladeira;
- Estufa (opcional);
- Termômetros;
- Micropipetas monocanal e multicanal de volumes reguláveis;
- Pipetador automático ou manual;
- Leitora de ELISA;
- Cronômetros;
- Agitador de tubos tipo vórtex (opcional);
- Agitador de microplacas (opcional);
- Lavadora de microplacas (opcional) e
- Autoclave.
Insumos
Kits de ELISA para a detecção de anticorpos para os micoplasmas aviários contemplados no PNSA.
Soluções
- No preparo das soluções deve ser utilizado somente os reagentes fornecidos pelo fabricante, ou aqueles por ele indicados;
- Conjugados, substratos e solução de parada deverão ser utilizados obedecendo-se as condições do fabricante;
- No preparo da solução de lavagem deve-se assegurar que não existem cristais precipitados na solução; e
- Diluir as soluções utilizando água ultrapura ou destilada conforme instruções do fabricante e homogeneizar bem.
Realização do ensaio
- Para realização dos ensaios de ELISA devem ser consideradas as orientações do fabricante do kit de diagnóstico utilizado. Atentar para ocorrência de atualização na bula do kit, principalmente em mudanças de lote;
- A ordem de execução das etapas do ensaio, duração, volumes utilizados e temperatura de incubação variam de acordo com fabricante do kit utilizado;
- Homogeneizar gentilmente todos reagentes e amostras antes do uso;
- Utilizar ponteiras distintas para cada controle e amostra de soro;
- Homogeneizar as placas tocando-as na lateral ou utilizando um agitador de placas;
- Nas etapas de incubação, as placas devem ser seladas para se evitar evaporação e incubadas na temperatura estabelecida pela bula do fabricante do kit;
- As placas devem ser lavadas com a solução indicada pelo kit. Após a última lavagem remover resíduos em um material absorvente (papel toalha ou toalha). Deixar as placas secas o mínimo de tempo possível entre a lavagem e adição do próximo reagente; e
- Decorridas todas as etapas do teste, realizar a leitura da absorbância na leitora de ELISA utilizando filtro com comprimento de onda indicado nas instruções do fabricante.
Critérios de aceitação do Ensaio
O resultado do ensaio será considerado válido somente se as Densidades Óticas (DOs) dos soros controles e os demais parâmetros calculados a partir delas estiverem dentro dos limites aceitáveis e determinados pelo fabricante. Caso contrário, o ensaio deve ser repetido.
Interpretação dos resultados
- De acordo com as DOs obtidas, consideram-se as amostras como POSITIVAS ou NEGATIVAS ou de acordo com o preconizado com o fabricante do insumo (kit de diagnóstico).
- Amostras com DO entre os dois pontos de corte estabelecidos serão consideradas inconclusivas e deverão ser novamente ensaiadas.
Emissão dos resultados
- Os resultados deverão ser emitidos e expresso como POSITIVO ou NEGATIVO ou de acordo com o preconizado com o fabricante do insumo (kit de diagnóstico).
- Expressar a quantidade de alíquotas positivas dentre o total de analisadas.
Descarte de Amostras e resíduos
- Antes da realização do descarte de amostras e produtos de ensaio deverão ser observados os prazos mínimos estabelecidos no item “Retenção de itens de ensaio”.
- Os materiais descartados devem ser separados adequadamente entre resíduos químicos e biológicos;
- Todo o resíduo biológico do ensaio deve ser submetido ao processo de autoclavação apropriado. A efetividade da esterilização deve estar comprovada em procedimentos próprios do laboratório e devem ser utilizados controles físicos, químicos e biológicos para o monitoramento do processo; e
- O laboratório deve assegurar a biossegurança dos resíduos gerados, e seguir as legislações ambientais vigentes durante todo o processo do descarte.
Retenção de itens de ensaio
Amostras de soro podem ser descartadas após um período mínimo de 30 dias da realização das análises, registrando-se em formulários próprios e conferidas antes do descarte.
¶ B. Detecção da Resposta Imune - Soroaglutinação rápida em placa (SAR)
Materiais
- Luvas descartáveis;
- Placa de vidro (ou outro material rígido) quadriculada;
- Ponteiras descartáveis;
- Bastões de vidro ou misturador múltiplo para homogeneizar; e
- Recipientes para descarte.
Equipamentos e instrumentos
- Micropipeta de volume regulável;
- Banho-maria, estufa ou termobloco;
- Fonte de luz;
- Cronômetro;
- Microcentrífuga; e
- Autoclave.
Insumos
- Antígeno corado para SAR; e
- Controle POSITIVO e NEGATIVO para SAR.
Soluções
- Solução salina 0,9% ou solução de PBS 0,01M pH 7,0-7,2.
Realização do ensaio
Preparo das amostras
- Este ensaio não pode ser realizado com amostras que foram congeladas; e
- Deixar as amostras atingirem temperatura ambiente (18 a 25°C) ou a temperatura indicada pela bula do fabricante do Antígeno antes de realizar o ensaio.
Preparo dos reagentes SAR
- Homogeneizar o frasco contendo o antígeno constantemente durante a realização do ensaio para evitar precipitação. Os antígenos devem estar na temperatura ambiente (18 a 25°C).
Soro Aglutinação Rápida - SAR
- Realizar o ensaio à temperatura ambiente (18 a 25°C) ou conforme indicação do fabricante;
- Homogeneizar suavemente o frasco contendo o antígeno durante a realização do ensaio para evitar precipitação;
- Depositar 20 µL ou o volume indicado pelo fabricante do antígeno no centro de um quadradinho da placa limpa e desprezar a ponteira;
- Depositar mesma quantidade do soro a ser testado sobre a gota do antígeno e homogeneizar ambas com auxílio de ponteira, bastão ou homogeneizador múltiplo, formando um círculo de aproximadamente 1,5 cm de diâmetro;
- Agitar suavemente a placa, fazendo movimentos circulares;
- Observar a formação de grumos colocando a placa contra a fonte luminosa e fundo branco após transcorrido o tempo especificado pelo fabricante;
- As amostras que apresentarem qualquer grau de aglutinação nessa etapa são consideradas reagentes e devem ser testadas na diluição para 1:4. Para isso, inativar as amostras em banho-maria a 56 ± 1ºC por 30 minutos, em seguida, diluir uma parte da amostra em 3 partes de solução salina 0,9% ou solução de PBS 0,01M pH 7,0-7,2; e
- Em paralelo às amostras, devem sempre ser incluídos:
- Soro controle POSITIVO; e
- Soro controle NEGATIVO.
Critérios de aceitação do ensaio
O ensaio será válido quando:
- O controle POSITIVO apresentar formação de grumos sob as condições especificadas para o ensaio pelo fabricante do insumo; e
- O controle NEGATIVO não apresentar nenhuma formação de grumos.
Interpretação dos resultados
- Considerar a amostra positiva quando houver qualquer grau de formação de grumos, dentro do tempo preconizados pelo fabricante, ainda que com menor intensidade que o controle POSITIVO, na diluição 1:4; e
- Considerar a amostra negativa quando não houver qualquer grau de formação de grumos.
Emissão dos resultados
- Os resultados deverão ser e expressos como “POSITIVO” ou “NEGATIVO”, ou de acordo com o preconizado pelo fabricante; e
- Expressar a quantidade de alíquotas positivas dentre o total de analisadas.
Descarte das amostras e Resíduos
- Os materiais descartados devem ser separados adequadamente entre resíduos químicos e biológicos;
- Antes da realização do descarte de amostras e produtos de ensaio deverão ser observados os prazos mínimos estabelecidos no item “Retenção de itens de ensaio”.
- Todo o resíduo biológico do ensaio deve ser submetido ao processo de autoclavação apropriado. A efetividade da esterilização deve estar comprovada em procedimentos próprios do laboratório e devem ser utilizados controles físicos, químicos e biológicos para o monitoramento do processo; e
- O laboratório deve assegurar a biossegurança dos resíduos gerados, e seguir as legislações ambientais vigentes durante todo o processo do descarte.
Retenção de itens de ensaio
- As amostras de soros poderão ser descartadas após um período mínimo de 72 horas após realização das análises, e ciência pelo demandante, registrando-se em formulários próprios e conferidas antes do descarte.
- Caso a mostras seja submetida a outro ensaio onde exista a previsão de seu armazenamento por tempo superior as 72 horas o maior prazo deverá ser respeitado.
¶ C. PCR convencional para micoplasma
Nota: O laboratório pode optar por realizar a técnica de PCR com um kit comercial ou protocolo in house. Ambos necessitam de comprovação de desempenho.
Materiais
- Luvas de procedimento nitrílicas ou de látex isentas de pó;
- Microtubos de volumes variados ou microplacas;
- Microplacas ou microtubos para PCR;
- Tampas adesivas para microplacas;
- Ponteiras com filtro, estéreis, livres de DNAses e RNAses;
- Estantes para microtubos;
- Jarra de anaerobiose ou outro dispositivo de microaerofilia; e
- Gaze ou papel toalha.
Equipamentos e instrumentos
- Cabine de segurança biológica com filtro HEPA classe II ou estação de trabalho para PCR (Workstation PCR) com luz UV germicida;
- Geladeira;
- Freezer;
- Micropipetas mono e multicanais de volumes reguláveis;
- Termociclador;
- Centrífuga para microtubos;
- Agitador de microtubos;
- Microcomputador;
- Fotodocumentador;
- Cubas de eletroforese;
- Equipamento para extração automatizada de ácidos nucleicos (opcional); e
- Autoclave.
Insumos
- Água livre de nucleases;
- Tubos com Caldo Frey Modificado para Micoplasma;
- Kit de extração de DNA;
- Solução tampão para PCR;
- Solução de cloreto de magnésio para PCR;
- Mix de dNTP;
- Primers forward e reverse para PCR específicos para MG, MS e MM;
- Enzima Taq DNA Polimerase;
- Controles “POSITIVOS” para MG, MS e MM (antígeno ou cultura de referência);
- Corante para ácidos nucleicos;
- Marcador de peso molecular;
- Tampão de carregamento (“loading buffer”);
- Gel de agarose; e
- Sugestão de oligonucleotídeos apresentados no QUADRO 1.
QUADRO 1: Sugestão de oligonucleotídeos para detecção molecular de Micoplasma
| Agente | Oligonucleotídeo | Tipo de PCR | Sequência | Referência |
| Mycoplasma gallisepticum | MG-F | PCR | 5' gga tcc cat ctc gac cac gag aaa a 3' | Nascimento et al, 1991 |
| MG-R | PCR | 5' ctt tca atc agt gag taa ctg atg a 3' | Nascimento et al, 1991 | |
| MG mgc2 F | qPCR | 5’ TTG GGT TTA GGG ATT GGG ATT 3’ | Raviv & Kleven, 2009 | |
| MG mgc2 R | qPCR | 5’ CCA AGG GAT TCA ACC ATC TT 3’ | Raviv & Kleven, 2009 | |
| MG mgc2 probe | qPCR | 5’ TexRd-XN TGA TGA TCC AAG AAC GTG AAG AAC ACC 3’ BHQ_2 | Raviv & Kleven, 2009 | |
| Mycoplasma synoviae | MS-F | PCR | 5' GAG AAG CAA AAT AGT GAT 3' | Lauerman et al, 1995 |
| MS-R | PCR | 5' cag tcg tct ccg aag tta aca a 3' | Lauerman et al, 1995 | |
| MS 16S-23S F | qPCR | 5’ CTA AAT ACA ATA GCC CAA GGC AA 3’ | Raviv & Kleven, 2009 | |
| MS 16S-23S R | qPCR | 5’ CCT CCT TTC TTA CGG AGT ACA 3’ | Raviv & Kleven, 2009 | |
| MS 16S-23S probe | qPCR | 5’ 6-FAM AGC GAT ACA CAA CCG CTT TTA GAA T 3’ BHQ_1 | Raviv & Kleven, 2009 | |
| Mycoplasma meleagridis | MM-F | qPCR | 5' - cga gcg aag ttt ttc gga ac-3' | Boyle, Good & Morrow, 1995 |
| MM-R | qPCR | 5' - ggt acc gtc agg ata aat gc-3' | Boyle, Good & Morrow, 1995 | |
| MM 16S-23S F | qPCR | 5’ AAC AAG GTA TCC CTA CGA GAA C 3’ | Raviv & Kleven, 2009 | |
| MM 16S-23S R | qPCR | 5’ CTC AGA GCC TTA AAC CAA GTC A 3’ | Raviv & Kleven, 2009 | |
| MM 16S-23S probe | qPCR | 5’ 6-FAM CCT CCT TTC TAC GGA GTA CAT TAG TT 3’ BHQ_1 | Raviv & Kleven, 2009 |
Soluções
- Solução de álcool 70º INPM;
- Solução descontaminante de moléculas residuais de RNAs / DNAs / amplicons /resíduos de proteínas de superfícies, entre as quais DNAses/RNAses; e
- Solução de hipoclorito de sódio 0,5%.
Realização do ensaio
Pré-enriquecimento das amostras
A etapa de incubação (pré-enriquecimento) poderá ser facultativa caso o laboratório possua um método de PCR validado com limite de detecção tão eficiente quanto o método com a extração após essa etapa.
Suabes de traqueia
- Homogeneizar os tubos contendo suabes de traqueia imersos em Caldo Frey; e
- Incubar os frascos de Caldo Frey em microaerofilia a 37 ± 1 °C por 72 horas ou até a acidificação do meio (coloração laranja ou amarela), caso ocorra antes desse período.
Traqueia
- Macerar/picotar/homogeneizar e inocular uma fração do pool em Caldo Frey, próximo ao bico de Bunsen ou dentro de cabine de segurança biológica; e
- Incubar os frascos de Caldo Frey em jarra de anaerobiose em microaerofilia ou em estufa de produção de CO2 a 37 ± 1 °C por 72 horas ou até a acidificação do meio (coloração laranja ou amarela), caso ocorra antes desse período.
Extração de ácidos nucleicos
- Realizar a extração de ácidos nucleicos das amostras incubadas, de forma automatizada ou manual, através de kits de extração de DNA específicos para o tipo de material a ser analisado, seguindo as recomendações do fabricante;
- O laboratório pode optar pelo uso de outro método de extração que não use kit, desde que apresente verificação de desempenho comprovada pelo próprio laboratório; e
- Adicionar as seguintes amostras controle a cada procedimento de extração: controle POSITIVO (MG, MS e/ou MM) e controle NEGATIVO (caldo Frey ou água).
Reação de amplificação de ácido nucleico por PCR
- Realizar o ensaio em duas áreas separadas: uma para o preparo do mix de reação (sala de pré-PCR) isenta de material genético e amplicons, e outra para a transferência de DNA para placa ou microtubos (sala de PCR);
- Antes e após o preparo do mix de reação, descontaminar a cabine e os materiais a serem utilizados com solução descontaminante de moléculas residuais de RNAs / DNAs / amplicons /resíduos de proteínas de superfícies, entre as quais DNAses/RNAses;
- Álcool 70º INPM; e
- As micropipetas utilizadas para o preparo do mix de reação e adição das amostras devem ser exclusivas para tais finalidades.
Preparo do mix de reação
- Preparar o mix de reação de acordo com protocolos validados e específicos para o agente pesquisado (Mycoplasma) em quantidade suficiente para o número de amostras a serem testadas, considerando algumas a mais;
- Adicionar o mix de reação a cada poço da microplaca (ou microtubos);
- Devem ser incluídos nas análises:
- Controle DETECTADO para Mycoplasma;
- Controle NÃO DETECTADO da extração;
- Branco (água livre de nucleases); e
- Controle DETECTADO e NÃO DETECTADO do kit utilizado (se houver).
Reação de PCR
- Após o preparo do mix, adicionar o DNA nos poços da placa ou em microtubos identificados com a numeração da amostra a ser testada; e
- Realizar a amplificação em termociclador certificado, conforme as especificações de temperatura do protocolo utilizado.
Eletroforese
- Preparar o gel de agarose em concentração adequada ao protocolo de PCR utilizado. Adicionar um corante para ácidos nucleicos em proporção suficiente para visualização das bandas;
- Para a corrida das amostras, adicionar tampão de carregamento (loading buffer) ao produto de PCR;
- Aplicar marcador de peso molecular em um dos poços do gel;
- Realizar a corrida em cuba de eletroforese, utilizando o tempo e a voltagem adequados para o volume do gel e o protocolo de PCR utilizado; e
- Visualizar o gel sob luz ultravioleta, fotografar com o auxílio de um fotodocumentador e analisar o resultado.
Critérios de aceitação do ensaio
- As amostras de controle POSITIVO para MG, MS e MM devem apresentar bandas de tamanhos correspondentes aos amplicons do protocolo utilizado; e
- As amostras de controle NEGATIVO (controle NEGATIVO da extração e branco) não devem apresentar bandas de amplificação.
Interpretação dos resultados
- Comparar os resultados das amostras testadas ao das amostras controle, a fim de classificá-las como positivas ou negativas;
- A leitura das bandas deve ser clara e livre de amplicons inespecíficos para o teste ser considerado satisfatório; e
- Qualquer amostra questionável deverá ser retestada.
Emissão dos resultados
- Os resultados deverão ser emitidos e expresso como “POSITIVO” ou “NEGATIVO”, ou de acordo com o preconizado pelo fabricante; e
- Expressar a quantidade de alíquotas positivas dentre o total de analisadas.
Descarte das amostras e resíduos
- Antes da realização do descarte de amostras e produtos de ensaio deverão ser observados os prazos mínimos estabelecidos no “Retenção de itens de ensaio”;
- Os materiais descartados devem ser separados adequadamente entre resíduos químicos e biológicos;
- Todo o resíduo biológico do ensaio deve ser submetido ao processo de autoclavação apropriado. A efetividade da esterilização deve estar comprovada em procedimentos próprios do laboratório e devem ser utilizados controles físicos, químicos e biológicos para o monitoramento do processo; e
- O laboratório deve assegurar a biossegurança dos resíduos gerados, e seguir as legislações ambientais vigentes durante todo o processo do descarte.
Retenção de itens de ensaio
Suabes de traqueia e traqueia
Amostras podem ser descartadas após um período mínimo de 30 dias da realização das análises, registrando-se em formulários próprios e conferidas antes do descarte.
Produtos de extração
Imediatamente após a emissão do laudo, as amostras poderão ser descartadas, registrando-se em formulários próprios e conferidas antes do descarte
¶ D. PCR em tempo real para micoplasma (qPCR)
Nota: O laboratório pode optar por realizar a técnica de PCR em tempo real com um kit comercial ou protocolo “in house”. Ambos necessitam de comprovação de desempenho.
Materiais
- Luvas de procedimento nitrílicas ou de látex isentas de pó;
- Microtubos de volumes variados ou microplacas;
- Microplacas ou microtubos para leitura óptica de qPCR;
- Tampas adesivas para microplacas para leitura óptica de qPCR;
- Ponteiras com filtro, estéreis, livres de DNAses e RNAses;
- Estantes para microtubos;
- Jarra de anaerobiose ou outro dispositivo de microaerofilia; e
- Gaze ou papel toalha.
Equipamentos e instrumentos
- Cabine de segurança biológica com filtro HEPA classe II ou estação de trabalho para PCR (Workstation PCR) com luz UV germicida;
- Geladeira;
- Freezer;
- Micropipetas mono e multicanais de volumes reguláveis;
- Termociclador para PCR em tempo real;
- Centrífuga para microtubos;
- Agitador de microtubos;
- Microcomputador;
- Equipamento para extração automatizada de ácidos nucleicos (opcional); e
- Autoclave.
Insumos
- Tubos com Caldo Frey Modificado para micoplasma;
- Controle POSITIVO para micoplasma específicos para MG, MS e MM;
- Água livre de nucleases;
- Kit de extração de DNA;
- Kit comercial para detecção de micoplasma por qPCR; ou
- Oligonucleotídeos (primers) e sondas específicos para detecção dos micoplasmas contemplados no PNSA (sugestão de oligonucleotídeos apresentada no QUADRO 1).
Soluções
- Solução de álcool 70º INPM;
- Solução descontaminante de moléculas residuais de RNAs / DNAs / amplicons /resíduos de proteínas de superfícies, entre as quais DNAses/RNAses; e
- Solução de hipoclorito de sódio 0,5%.
¶ Realização do ensaio
Pré-enriquecimento das amostras
A etapa de incubação (pré-enriquecimento) poderá ser facultativa caso o laboratório possua um método de PCR validado com limite de detecção tão eficiente quanto o método com a extração após essa etapa.
Suabes de traqueia
- Homogeneizar os tubos contendo suabes de traqueia imersos em Caldo Frey; e
- Incubar os frascos de Caldo Frey em microaerofilia a 37 ± 1 °C por 72 horas ou até a acidificação do meio (coloração laranja ou amarela), caso ocorra antes desse período.
Traqueia
- Macerar/picotar/homogeneizar e inocular uma fração do pool em Caldo Frey, próximo ao bico de Bunsen ou dentro de cabine de segurança biológica; e
- Incubar os frascos de Caldo Frey em jarra de anaerobiose em microaerofilia ou em estufa de produção de CO2 a 37 ± 1 °C por 72 horas ou até a acidificação do meio (coloração laranja ou amarela), caso ocorra antes desse período.
Extração de ácidos nucleicos
- Realizar a extração de ácidos nucleicos das amostras incubadas, de forma automatizada ou manual, através de kits de extração de DNA específicos para o tipo de material a ser analisado, seguindo as recomendações do fabricante;
- O laboratório pode optar pelo uso de outro método de extração que não use kit, desde que apresente verificação de desempenho comprovada pelo próprio laboratório; e
- Adicionar as seguintes amostras controle a cada procedimento de extração: controle POSITIVO (MG, MS e/ou MM) e controle NEGATIVO (caldo Frey ou água).
Reação de amplificação de ácido nucleico por qPCR
- Realizar o ensaio em duas áreas separadas: uma para o preparo do mix de reação (sala de pré-PCR) isenta de material genético e amplicons, e outra para a transferência de DNA para placa ou microtubos (sala de PCR);
- Antes e após o preparo do mix de reação, descontaminar a cabine e os materiais a serem utilizados com Solução descontaminante de moléculas residuais de RNAs / DNAs / amplicons /resíduos de proteínas de superfícies, entre as quais DNAses/RNAses;
- Álcool 70º INPM; e
- As micropipetas utilizadas para o preparo do mix de reação e adição das amostras devem ser exclusivas para tais finalidades.
Preparo do mix de reação
- Preparar o mix de reação de acordo com protocolos validados e específicos para o agente pesquisado (Mycoplasma spp.) em quantidade suficiente para o número de amostras a serem testadas, considerando algumas a mais;
- Após o preparo do mix, adicionar o DNA nos poços da placa ou em microtubos para leitura óptica;
- A adição de DNA e das amostras controle deve ser realizada em uma área distinta do preparo do mix (sala de PCR);
- Devem ser incluídos no ensaio:
- Controles “POSITIVOS” para MG, MS e/ou MM;
- Controle NÃO DETECTADO da extração;
- Branco (água livre de nucleases); e
- Controle DETECTADO e NÃO DETECTADO do kit utilizado (se houver).
Reação de qPCR
- Selar a placa com adesivo óptico ou fechar a tampa dos microtubos. Verificar se há bolhas no fundo do poço e/ou gotículas na parede dos poços da placa ou tubo. Caso isto ocorra, centrifugar brevemente para reduzir as bolhas e para que o conteúdo se posicione na parte inferior da placa ou tubo;
- Iniciar e entrar com os dados no software do termociclador (identificação das amostras e seleção dos fluoróforos), conforme especificações do fabricante;
- Inserir a placa ou os tubos no termociclador, salvar o arquivo e iniciar a corrida; e
- Ao finalizar, salvar os dados e interpretar os resultados.
Critérios de aceitação do ensaio
- Para a validação do ensaio, o controle POSITIVO do kit e o controle interno devem apresentar uma curva sigmoide (em forma de S) e um Cq satisfatório (conforme especificações do fabricante); e
- O controle NEGATIVO deve ter Cq indeterminado ou maior que o limite do kit. O gráfico do controle NEGATIVO deve apresentar traços de fluorescência na linha de base durante todo o ensaio. Esses traços não devem apresentar curva sigmoide ou um aumento gradual na fluorescência.
Interpretação dos resultados
- Ao analisar os resultados da corrida, o operador deve avaliar os seguintes componentes: controle POSITIVO, controle NEGATIVO, controle da extração, background de fluorescência e gráficos de amplificação de cada amostra individualmente;
- Após a validação do ensaio, interpretar os resultados conforme especificações do fabricante; e
- Qualquer amostra questionável deverá ser retestada.
Emissão dos resultados
- Os resultados deverão ser emitidos e expresso como POSITIVO ou “NEGATIVO”, ou de acordo com o preconizado pelo fabricante; e
- Expressar a quantidade de alíquotas positivas dentre o total de analisadas.
Descarte das amostras e resíduos
- Antes da realização do descarte de amostras e produtos de ensaio deverão ser observados os prazos mínimos estabelecidos no “Retenção de itens de ensaio”;
- Os materiais descartados devem ser separados adequadamente entre resíduos químicos e biológicos;
- Todo o resíduo biológico do ensaio deve ser submetido ao processo de autoclavação apropriado. A efetividade da esterilização deve estar comprovada em procedimentos próprios do laboratório e devem ser utilizados controles físicos, químicos e biológicos para o monitoramento do processo; e
- O laboratório deve assegurar a biossegurança dos resíduos gerados, e seguir as legislações ambientais vigentes durante todo o processo do descarte.
Retenção de Itens de Ensaio
Suabes de traqueia e traqueia
Amostras podem ser descartadas após um período mínimo de 30 dias da realização das análises, registrando-se em formulários próprios e conferidas antes do descarte.
Produtos de extração
Imediatamente após a emissão do laudo, as amostras poderão ser descartadas, registrando-se em formulários próprios e conferidas antes do descarte
¶ 5. Base legal e documentos de referência
¶ Salmonelose
- DUARTE, S. C. et al. Guia ilustrado para isolamento de Salmonella spp. de origem avícola. Concórdia: Embrapa Suínos e Aves, 2016. 73 p.; 21 cm.
- Fowl typhoid and Pullorum disease. Chapter 3.3.11. Version (NB: version adopted in May 2018). Manual of Diagnostic Tests and Vaccines for Terrestrial Animals, 2023, versão online. Disponível em: https://www.woah.org/en/what-we-do/standards/codes-and-manuals/terrestrial-manual-online-access/. Acesso em: 11 jan. 2024.
- GRIMONT, P.A.D.; WEILL, F.X. Antigenic formulae of the Salmonella Serovars. 9th ed. Paris: Institut Pasteur, 2007. WHO Collaborating Center for Reference and Research on Salmonella. Disponível em: < https://www.pasteur.fr/sites/default/files/veng_0.pdf>. Acesso em: 10 dez. 2020.
- International Air Transport Association (IATA). Dangerous Goods Regulations. 61st Edition. 2020.
- International Standard Organization (ISO). ISO 6579-1:2017. Microbiology of the food chain — Horizontal method for the detection, enumeration and serotyping of Salmonella — Part 1: Detection of Salmonella spp. 2017.
- International Standard Organization (ISO). ISO 6579-3:2014. Microbiology of the food chain — Horizontal method for the detection, enumeration and serotyping of Salmonella — Part 3: Guidelines for serotyping of Salmonella spp. 2014.
- LÁZARO, N.S.; REIS, E.M.F.; PEREIRA, C.S.; RODRIGUES, D.P. Manual Gênero Salmonella: Características Epidemiológicas e Laboratoriais. Rio de Janeiro: FIO CRUZ, 2008. 67 p.
- MALORNY, B; PACCASSONI, E; FACH, P; BUNGE, C; MARTIN, A; HELMUTH, R. “Diagnostic Real-Time PCR for Detection of Salmonella in Food”. Applied and environmental microbiology, Dec. 2004, Vol. 70, No. 12, p. 7046-7052.
- Salmonellosis. Chapter 3.10.7. Version (NB: version adopted in May 2022). Manual of Diagnostic Tests and Vaccines for Terrestrial Animals, 2023, versão online. Disponível em: https://www.woah.org/en/what-we-do/standards/codes-and-manuals/terrestrial-manual-online-access/. Acesso em: 11 jan 2024.
- SZMOLKA A, KASZANYITZKY E, NAGY B. “Improved diagnostic and real-time PCR in rapid screening for Salmonella in the poultry food chain”. Acta Vet Hung. 2006 Sep;54 (3):297- 312.
¶ Micoplasmose Aviária
- Avian mycoplasmosis (Mycoplasma gallisepticum, M. synoviae). CHAPTER 3.3.5. Version (NB: version adopted in May 2021). Manual of Diagnostic Tests and Vaccines for Terrestrial Animals, 2021, versão online. Disponível em: https://www.woah.org/en/what-we-do/standards/codes-and-manuals/terrestrial-manual-online-access/. Acesso em: 11 jan. 2024.
- BOYLE JS, GOOD RT, MORROW CJ. “Detection of the Turkey Pathogens Mycoplasma meleagridis and M. iowae by Amplification of Genes Coding for rRNA”. Journal of Clinical Microbiology, Vol. 33, No. 5 (1995), pp. 1335–1338.
- LAUERMAN LH, CHILINA AR, CLOSSER, JA AND JOHANSEN D. “Avian Mycoplasma Identification Using Polymerase Chain Reaction Amplicon and Restriction Fragment Length Polymorphism Analysis”. Avian Diseases, Vol. 39, No. 4 (1995), pp. 804-811.
- NASCIMENTO ER, YAMAMOTO R, HERRICK KR, TAIT RC. “Polymerase chain reaction for detection of Mycoplasma gallisepticum”. Avian Dis. 1991 Jan-Mar;35(1):62-9.
- RAVIV Z, KLEVEN SH. “The development of diagnostic real-time TaqMan PCRs for the four pathogenic avian mycoplasmas”. Avian Dis. 2009 Mar;53(1):103-7.
¶ 6. Disposições Gerais
As sugestões para aprimoramento ou possíveis correções deste documento devem ser direcionadas ao Departamento responsável, para alinhamento das melhores práticas de mercado, legislação vigente e/ou regulamentações, que não tenham sido contempladas na versão vigente.
¶ 7. Histórico de revisões
| Versão | Conteúdo alterado | Data | Motivo |
|---|---|---|---|
| 1 | -//- | 03.10.2024 | Elaboração do documento |
| 2 | Método D. Identificação de agente - Isolamento de Salmonela - Figura 1 | 10.02.2025 | Ajuste do documento |
¶ 8. Anexos
¶ 8.1 ANEXO – Fluxograma de processamento de amostras não sorológicas de salmonela

a. A técnica de PCR em tempo real para Salmonella spp. e para sorovares específicos do PNSA pode ser realizada após qualquer etapa do início do isolamento, de acordo com a verificação de desempenho realizada pelo laboratório;
b. A técnica de Microarranjo de DNA pode ser realizada após quaisquer etapas do isolamento a partir da purificação da colônia ou da inoculação em ágar MSRV, de acordo com o protocolo do laboratório e orientações do fabricante do kit.
* O laboratório deve optar pela técnica de caracterização antigênica de preferência: inoculação em ágar sólido (com ou sem salina) ou inoculação em ágar semi-sólido; e pela técnica de inversão de fase de preferência: técnica da fonte de papel ou em ágar semi-sólido.